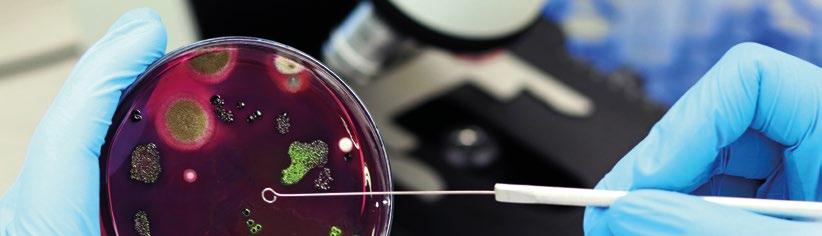
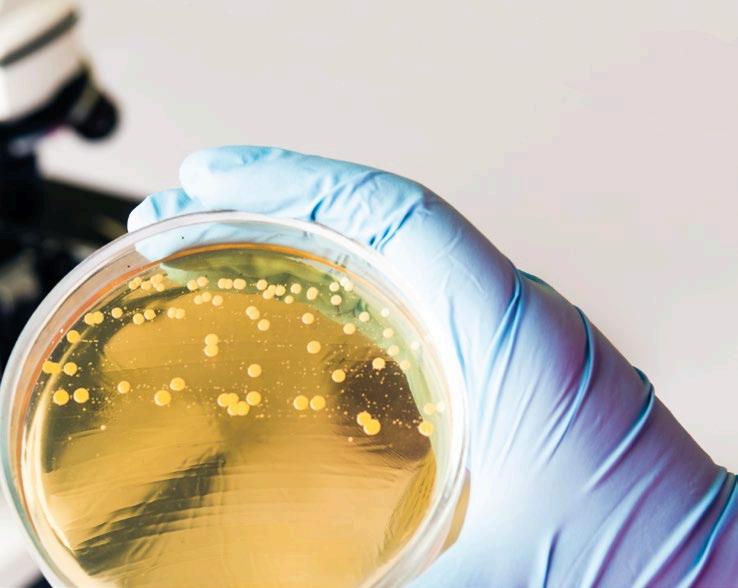

![]()






Cumplimiento de la bioseguridad: el equilibrio entre cultura, personalidad, experiencia, educación y tecnología
Edgar O. Oviedo Rondon North Carolina State University
Agregar valor con un deshuesado flexible de pechuga
Equipo Técnico BAADER


Depresión, velocidad del aire y la trayectoria del aire entrante
Michael Czarick y Brian Fairchild Department of Poultry Science - UGA
Manejo de huevos en el suelo en reproductoras de pollos de engorde
Equipo Técnico Cobb-Vantress

Basquetbol- Reglas que pueden ayudar a mejorar la productividad integral durante la prefaena y el procesamiento de los pollos
Eduardo Cervantes López
Consultoría Internacional - Gerencia Productiva e Innovadora en Procesamiento de Aves

Desafíos para el mantenimiento de la ventana de nacimiento
Renata Steffen
Consultora en incubación industrial
54


El cobre y sus funciones en la dieta de las gallinas ponedoras: Ventajas de la forma quelada
Vinício dos Santos Cardoso y Tatiana Carlesso dos Santos Universidade Estadual de Maringá
68

60
Adaptando la bioseguridad en periodos de alto riesgo Influenza Aviar- Parte II
Equipo Técnico H&N International
72

Detección temprana de deficiencias nutricionales y enfermedades
José Francisco Miranda Jr. Gerente de Servicios de Precisión Contenido de DSM
E. Coli Patogénica Aviar (APEC): Serotipos y virulencia
Dra. Cecilia Rosario Cortés


80

Influenza Aviar, el cambio es lo único constante
Lesly Romero Beltrán
Gerente División Comercial Aves Contenido de Sanfer Salud Animal
102

86

Infección por estafilococo en la población de reproductoras – Parte II
Eric L. Jensen
DVM, MAM, diplomado de la ACPV, y Dra. Carolyn L. Miller, DVM, MAM, diplomada de la ACPV (2001).
Revisado por Jose J. Bruzual, DVM, MAM, MSc, diplomado del APCV, PAS Contenido de Aviagen
94


Desafíos actuales de micotoxinas en Latinoamérica
M.V. Bruno Vecchi1 y M.V. Cecilia Rodríguez 2
1Gerente Técnico Avícola
2Redactora Técnica Contenido de Vetanco
Gestión integral de la producción de pollo de engorde: Contribuyendo a la rentabilidad de la empresa. Parte II
Ing. Jorge Robles
Gerente General de Producción Redondos S.A. Perú













El hombre es un animal esencialmente carnívoro, condenado muchas veces al vegetarismo económico. (Países pobres).
El creciente apetito por la carne en el mundo
De acuerdo a la base de datos estadísticos corporativos de la Organización de las Naciones para la Alimentación y la Agricultura, FAOSTAT, la producción mundial de carne en 2024 (en millones de toneladas), se distribuyó de la siguiente manera: Carne de Ave: 143 millones; Carne de Cerdo: 122 millones; Carne Bovina: 76 millones; Carne Ovina: 17 millones
La carne de ave, la reina del mundo
Como se esperaba desde el año del 2020, la producción y consumo de carne de pollo rebasó la producción mundial y el consumo de carne de cerdo a nivel mundial. Esto significa que desde hace cinco años, la especie humana, se ha alimentado fundamentalmente de carne de pollo, superando ampliamente el consumo de la carne de cerdo, bovina, pavo y de ovicaprinos.
Principales países productores y consumidores de pollo
Productores Consumidores
EE.UU. 20,992 56.2
Brasil 14,485 52.0
China 14,300 51.0
Unión Europea 10,970 49.3 *
México 4,060 49.2
Tailandia 3,430 45.1
Turquía 2,418 40
Argentina 2,338 37.5
Colombia 1,395 36.5
Perú 1,375 36.3
EE.UU.
Australia Perú
Argentina Malasia Brasil Bélgica Canadá México
Colombia
FAOSTAT. 2024. (Miles de toneladas)
FAOSTAT. 2024. (Kg per cápita/año)
*Superando por vez primera el consumo de la carne bovina en Argentina, el cual fue de 44.8 kilos per cápita/annum.
Con respecto a la carne de pollo el consumo mundial anual per cápita en el 2024, fue de 10.4 kilos habitante/año con una producción de 1,829,000 millones de cabezas y un crecimiento anual del 3.0%.
Principales países productores de huevo entero en el mundo
Productores Consumidores
Nueva Zelanda
Estados Unidos
Finlandia
Chipre
Irán
International Egg Commission. Miles de cajas
FAOSTAT. 2024. (Kg/per cápita/año)
*México es una gran potencia avícola, con un consumo anual de 461 huevos por persona en 2024, lo que equivale a 25.6 kilos, el más alto del mundo. Además, cuenta con una parvada de 171 millones de gallinas en producción y un crecimiento anual del 4.6%.
Sin duda alguna, durante el siglo XXI la industria pecuaria de mayor relevancia que más producirá proteína de origen animal será la industria avícola en América Latina, Norteamérica y en el resto del mundo. En realidad es el continente americano, que se ha convertido en el gran productor de productos avícolas , debido a la enorme producción de carne de ave y huevo con la que contribuyen países como son los Estados Unidos de América, Brasil y México, gigantes avícolas, acompañados por las industrias avícolas de Argentina, Colombia, Perú, Chile, Ecuador, Bolivia, Paraguay, Uruguay y Centroamérica.
“La Humanidad se alimentará fundamentalmente de proteínas de origen aviar durante el siglo XXI”.
De ahí la gran importancia de la Industria Avícola Latinoamericana y Mundial.

EDITOR GRUPO DE COMUNICACIÓN AGRINEWS S.L.
PUBLICIDAD
Miguel Martín Tamayo +34 664 660 603 sales@grupoagrinews.com
Karla Bordin +55 (19) 98177-2521 mktbr@grupoagrinews.com
Luis Carrasco +34 605 09 05 13 lc@agrinews.es
Nicole Carletti +57 312 391 9330 avinewslatam@grupoagrinews.com
ATENCIÓN AL CLIENTE Mercé Soler
REDACCIÓN
José Luis Valls
Daniela Morales
Maria de los Angeles Gutiérrez Nicole Carletti
DIRECCIÓN TÉCNICA
Dr. Miguel A. Márquez, DVM, MSc, PhD, Diplomate ACPV Patólogo Aviar/Avian Pathologist FMVZ/UNAM
Ing. Eduardo Cervantes
Consultor internacional de procesamiento avícola
Dr. Guillermo Díaz Arango Consultor técnico internacional en gallinas de postura
Mário Penz Jr. Winfridus Bakker
Juan Carlos López
Mike Czarick Brian Fairchild
COLABORADORES info@grupoagrinews.com avinews.com
Revista de distribución gratuita DIRIGIDA A VETERINARIOS Y TÉCNICOS Depósito Legal Avinews B11597-2013
ISSN (Revista impresa) 2696-8223
ISSN (Revista digital) 2696-8231
Precio de suscripción anual: 90 USD
Miguel A. Márquez


Edgar O. Oviedo-Rondón
Prestage Department of Poultry Science, North Carolina State University. Raleigh, NC

Las enfermedades endémicas y emergentes continúan siendo una amenaza constante para la producción avícola, el bienestar y la economía de la industria avícola en todo el mundo. La prevención y el control de la Influenza Aviar Altamente Patógena (IAAP), la enfermedad de Newcastle y todas las demás enfermedades dependen principalmente de la implementación de programas completos de manejo de bioseguridad.

La bioseguridad abarca infraestructura, tecnologías, técnicas, manejo y prácticas básicas de higiene.
Si bien las instalaciones avícolas, las cercas y la ubicación de los equipos deben diseñarse para facilitar las prácticas de bioseguridad, la comunicación efectiva es siempre un factor crucial.
Convencer a todos los involucrados en el sistema de producción y a los potenciales visitantes de incorporar prácticas de bioseguridad en sus rutinas es una necesidad.

Las medidas de bioseguridad han sido objeto de debate en numerosas ocasiones. La bioseguridad eficaz depende de un cumplimiento estricto, constante y diario en la explotación y a nivel regional. Se ha informado de que el cumplimiento de las medidas de bioseguridad, como seguir constantemente los protocolos de sanitización, cambiar el calzado o respetar las zonas antes de entrar en una instalación de producción, reduce significativamente las enfermedades.
Lamentablemente, el bajo cumplimiento de la bioseguridad es un problema endémico en todo tipo de sistemas de producción animal en todo el mundo y es la principal razón por la que la bioseguridad puede no ser efectiva.
En todos los casos, el factor humano es crítico.
Muchos expertos en bioseguridad han concluido que para tener éxito en esta tarea es necesario crear una cultura de bioseguridad, abordar rasgos de personalidad, brindar experiencias y lo más importante, garantizar la educación continua.
También es crucial aplicar nuevas tecnologías para monitorear, auditar y garantizar la bioseguridad.
Sin embargo, es importante entender que ninguna intervención o acción correctiva por sí sola puede resolver el problema del bajo cumplimiento de la bioseguridad.
Los factores de comportamiento humano son cruciales para implementar una bioseguridad eficaz.
La falta de cumplimiento de la bioseguridad es tan frecuente en toda la industria animal que ha planteado la necesidad de una nueva área de investigación.
Una mejor comprensión del complejo proceso humano de toma de decisiones que influye en la voluntad de los trabajadores de cumplir con los protocolos de bioseguridad requiere enfoques de investigación y técnicas de recopilación de datos innovadores.
Los seres humanos deben participar en la estrategia, las tácticas y las operaciones, que están guiadas por un objetivo a largo plazo. Las cuestiones de bioseguridad a escala estratégica suelen estar relacionadas con las interacciones en red de personas ubicadas en diversas instalaciones y proveedores de servicios a lo largo de las cadenas de producción.

Toda persona que trabaje o preste un servicio en una instalación avícola debe comprender y seguir las reglas y los procedimientos.
A nivel táctico, los gerentes o propietarios de granjas deciden si invertir o no en protocolos de bioseguridad preventivos y aplicarlos. Desde una perspectiva más estrecha y localizada, la bioseguridad a nivel operativo se puede considerar como una serie continua de decisiones que toman los trabajadores de producción animal indicando su voluntad para seguir o cumplir con los protocolos de bioseguridad diarios.
Los niveles operacional, táctico y estratégico de la bioseguridad están interconectados.
Por ejemplo, la toma de decisiones tácticas influye en los protocolos de nivel operacional.
Además, si bien se sabe que el cumplimiento de la bioseguridad a nivel operacional afectará la implementación y la eficacia de las decisiones tácticas y estratégicas de bioseguridad, actualmente se dispone de información limitada que describa el comportamiento a nivel operacional para fundamentar la toma de decisiones a nivel táctico y estratégico.
La presión para completar el trabajo de manera eficiente con limitaciones de tiempo ha creado escenarios en los que a los trabajadores de la explotación les resulta extremadamente difícil completar sus trabajos y al mismo tiempo cumplir con las normas de bioseguridad.
Las investigaciones han sugerido que los avicultores de los Estados Unidos muestran tolerancia al riesgo, pero es más probable que implementen o cumplan con las medidas de bioseguridad a medida que aumenta el riesgo percibido de infección.

De hecho, a medida que aumentaba el riesgo real de infección, también lo hacía el cumplimiento de una práctica de bioseguridad.
También se espera que la certeza de la información sobre el riesgo de infección afecte la implementación y el cumplimiento de la bioseguridad por parte de los trabajadores.
Sin embargo, el efecto puede cambiar dependiendo del dominio de interés, es decir, táctico u operativo.












Las decisiones de los trabajadores a nivel operativo tienen consecuencias económicas y sociológicas directas cuando se produce un brote. Las señales sociales, toda la comunicación no verbal y los ejemplos darán lugar a diferentes estrategias de cumplimiento entre los individuos. El comportamiento de los demás, aunque no afecte directamente al individuo, afectará a su toma de decisiones para cumplir con las medidas de bioseguridad.
Entonces, los incentivos y las normas sociales juegan un papel esencial para mantener el cumplimiento.
Los trabajadores de una instalación para animales pueden estar expuestos a diversa información sobre las consecuencias de una infección animal.
Aún así, equilibran el costo de la infección con la complacencia y una tendencia a volverse laxos en las actividades cotidianas.
En general, se percibe que las visitas de corta duración a las instalaciones suponen amenazas menores y, en consecuencia, en estos casos se olvidan los procedimientos de bioseguridad, convirtiéndose en la causa más común de brotes.
Esta relajación de las medidas de bioseguridad se ha examinado desde una perspectiva temporal, y hay pruebas que sugieren que las personas consideran que la probabilidad y el impacto de un evento de enfermedad animal se reducen a medida que pasa el tiempo. En este concepto, denominado distanciamiento psicológico basado en el tiempo, cuanto más lejano en el tiempo ocurre un evento, menos probable e impactante se percibe que es.
Los estudios han indicado que los programas de capacitación continua, combinados con sesiones de capacitación específicas según las necesidades observadas, deberían abordar cuestiones relacionadas con las visitas de todo el personal avícola y los visitantes.
La capacitación debe enfatizar que los procedimientos de bioseguridad deben aplicarse con el mismo rigor independientemente de la duración y el momento de la visita.
La introducción de nuevos carteles con la lista de medidas de bioseguridad requeridas por el productor puede mejorar el cumplimiento a corto plazo.
Pero es necesaria una rotación constante de la información.
La capacitación también debe abordar la noción de la percepción de amenazas cuando se adoptan conductas de protección, lo que implica inculcarles el concepto de que las enfermedades de los animales pueden afectarlos directamente en sus ingresos y en su propia salud.
Los estudios han demostrado que ser miembro de la familia de un productor mejora el cumplimiento de la bioseguridad. Sin embargo, siempre es necesario un rasgo de personalidad para cumplir con la bioseguridad.
Un estudio realizado por Racicot et al. (2012) identificó que el cumplimiento estaba asociado con personas que mostraban responsabilidad, complejidad y rasgos orientados a la acción.


Recientemente, Racicot et al. (2022) evaluaron dos tecnologías basadas en identificación por radiofrecuencia (RFID) para monitorear y mejorar continuamente el cumplimiento de la bioseguridad en las instalaciones avícolas.
Las botas de granja estaban equipadas con chips RFID colocados debajo de las suelas.
También se instalaron dos tapetes de presión (uno en el área sucia y otro en el área limpia) en la entrada del galpón para facilitar la detección de visitantes, evaluar la dirección de las personas (es decir, entrando o saliendo) y detectar una falta de cumplimiento si se registraban botas de granja en el área limpia (Figura 1).
Se conectaron tres antenas a la RFID en la entrada del galpón:
1
La primera en el marco de la puerta exterior que identifica a la persona que ingresa al galpón (tarjeta de acceso ya utilizada por los empleados),
2
La segunda en el área sucia, que permite detectar botas de granja con chip (que indica incumplimiento de bioseguridad), y
3
La tercera en el área limpia, conectada al desinfectante de manos, detectando la desinfección de manos al ingresar y salir del área limpia, así como los chips RFID en las botas de granja (que indican el cumplimiento del cambio de botas).
Los resultados confirmaron la capacidad del sistema RFID para monitorear el cumplimiento de la desinfección de botas y manos. Un sistema de monitoreo continuo parece mejorar el cumplimiento de la bioseguridad, con un porcentaje de cumplimiento de casi el doble en comparación con estudios anteriores que utilizaron cámaras ocultas.

Los participantes reaccionaron cada vez que sonó la alarma, a menudo preguntándose qué pudieron haber hecho mal.
Los participantes informaron que el sistema RFID estaba ayudando a aumentar el cumplimiento diario y recomendaron utilizarlo a mayor escala para mejorar el cumplimiento general. Asimismo, indicaron que se sentían cómodos con el uso de chips en los zapatos y que el proyecto no les parecía invasivo.
Figura 1. Sistema de monitoreo automatizado continuo en tiempo real basado en identificación por radiofrecuencia (RFID). (a) Chips blandos insertados en los zapatos de trabajo que usa el personal que llega a la granja; (b) Chips rígidos insertados en las suelas de las botas de la granja; (c) Antena RFID; (d) Dispositivo (e-box) con programa de gestión de datos; (e) Dispositivo desinfectante para manos. Fuente: Racicot et al., 2022 Front. Vet. Sci. z


El mismo grupo dirigido por Racicot y colaboradores había evaluado en 2012 cámaras ocultas en granjas avícolas de Quebec. Estas documentaron 44 fallas de bioseguridad cometidas por trabajadores y visitantes durante cuatro semanas.
La presencia de una cámara visible en la entrada del galpón mejoró el cumplimiento general de la visita, específicamente el cumplimiento de las normas de seguridad y de la zona.
Sin embargo, seis meses después de su instalación, el cumplimiento del área durante la visita fue la única medida de bioseguridad reforzada en la evaluación de mediano plazo.
Cumplimiento de la bioseguridad: el equilibrio entre cultura, personalidad, experiencia, educación y tecnología
DESCÁRGALO EN PDF
El cumplimiento disminuyó con el tiempo.
Las auditorías de bioseguridad no tuvieron ningún impacto en la mejora del cumplimiento diario de la bioseguridad cuando no había otra persona presente.
Estos resultados indican que un sistema automático de monitoreo y registro de las actividades de cada persona podría mejorar aún más el cumplimiento de la bioseguridad. Se necesita más innovación para implementar esta tecnología en otras prácticas de bioseguridad. Las tecnologías pueden ayudar a superar los desafíos que genera el factor humano en el cumplimiento de la bioseguridad.



BACTERICIDA
FUNGICIDA
ESPORICIDA
COCCIDICIDA


· Eficacia probada por normas UNE oficiales europeas.
· 100% Estable.
· 100% Biodegradable.
Michael Czarick 1 & Brian Fairchild 2
1UGA Extension Engineer
2UGA Extension Poultry Scientist
Traducción: Serafín García Freire

La ventilación con presión negativa es el método más popular para ventilar granjas avícolas en épocas frías debido a su simplicidad y a los costos iniciales relativamente bajos.


Los extractores crean presión negativa dentro del galpón y le dan al avicultor un control preciso sobre la cantidad de aire fresco que entra en el galpón.
Las entradas de aire distribuyen el aire frío exterior, aspirado por los extractores, uniformemente por todo el galpón y lo dirigen a lo largo del techo, donde el aire caliente (producido por las aves y el sistema de calefacción) se acumula cerca del techo; de forma que el aire fresco se calentará antes de bajar al nivel de las aves.
Una de las características más importantes de la ventilación por presión negativa es que le da al avicultor el control sobre la velocidad a la que el aire limpio y frío exterior entra en el galpón.

No importa si el galpón mide 30 o 200 metros de largo; No importa si el galpón tiene 9 o 18 metros de ancho; No importa si el galpón tiene pollos de carne, ponedoras, reproductoras o patos.
El objetivo durante el clima frío es maximizar la distancia que recorre el aire fresco entrante a lo largo del techo antes de bajar al nivel de las aves.
Cuanto más rápido entre el aire en el galpón, más tiempo permanecerá cerca del techo, más se mezclará con el aire caliente que se acumula cerca del techo y es menos probable que enfríe a las aves cuando descienda al suelo
Con unas entradas de aire adecuadas y el nivel adecuado de presión negativa, es relativamente sencillo proporcionar aire fresco y cálido a todas las aves de un galpón con un mínimo costo y esfuerzo.
Además, a medida que aumenta la temperatura del aire entrante, aumenta su capacidad para retener la humedad, lo que lo hace más eficaz para eliminar la humedad de la cama.
Si el aire frío y pesado que entra por las trampillas del galpón no entra con suficiente velocidad, tenderá a caer rápidamente al suelo al entrar en el galpón, lo que provocará que los pollitos se enfríen y la cama se apelmace.




Perfectamente adaptable a tus necesidades.

> Estructura de acero galvanizado: un gran equilibrio entre durabilidad y eficiencia en costos;
> Motor de transmisión directa para alta eficiencia y mínimo mantenimiento;
> Opcional: Persianas y red de seguridad para mayor versatilidad;
> Rendimiento superior en un diseño compacto

En ventilaciones por presión negativa, la depresión determina la velocidad de entrada de aire a través de las entradas de aire del galpón.
Cuanto mayor sea la depresión, más rápido entrará el aire en el galpón.
Cuanto menor sea la depresión, más lentamente entrará el aire en el galpón.

La relación entre la depresión y la velocidad de entrada de aire está muy bien definida.
De hecho, se puede conocer la depresión del galpón midiendo la velocidad del aire que entra en el galpón a través de una trampilla de la pared lateral y usando el Gráfico 1.

Gráfico 1. Relación entre la velocidad de entrada del aire y la depresión.
A menudo se piensa que el factor principal que determina la depresión óptima para un galpón es el ancho de este.
Es lógico que cuanto más ancha sea el galpón, mayor será la velocidad del aire requerida para que el aire entrante llegue al centro del galpón y, por lo tanto, mayor será la depresión requerida.
Pero, en realidad, el factor principal que determina la depresión óptima es el frío que hace afuera, o más concretamente, la diferencia de temperatura del aire entre el interior y el exterior del galpón.
Esto tiene sentido si consideramos por qué utilizamos entradas de aire... para mantener el aire frío y pesado cerca del techo, y que se caliente antes de bajar al suelo.
Si el aire entrante es cálido y relativamente ligero, ¿por qué se va a caer al suelo?
Después de todo, si tiene casi la misma temperatura que el aire caliente del galpón, no es más pesado que el aire del galpón, y, por tanto, tenderá a permanecer cerca del techo.
Ahora bien, si el aire entrante es mucho más frío y por tanto más pesado que el aire del galpón, tenderá a caer al suelo rápidamente, en el caso que entre en el galpón a baja velocidad.*

Se han desarrollado ecuaciones para predecir el alcance del aire a lo largo del techo que entra a través de una trampilla antes de bajar al nivel del suelo, en función de varios factores (como por ejemplo, presión estática, tamaño de la abertura de entrada, tipo de entrada, posición de la entrada, etc.).
Aunque no proporcionan respuestas precisas para cada situación, estas ecuaciones se pueden utilizar para explorar cómo factores como las diferencias de temperatura interior/exterior afectan a la trayectoria del aire entrante.
Por ejemplo, para una trampilla de estilo europeo típica colocada cerca de un techo liso, abierta 5 centímetros, a una presión estática de 27 pascales, la lámina de aire viajará aproximadamente 8 metros a lo largo del techo antes de bajar al nivel del suelo cuando la temperatura exterior sea de 21 oC y 27 oC en el interior (ver Tabla 1).
Pero si la temperatura exterior cae a -1 oC, ¡la distancia recorrida se reducirá a solo 3,3 metros!
*Nota del traductor: Sólo algunos modelos de ordenadores avícolas disponibles en el mercado español tienen la función de aumentar progresivamente la depresión del galpón (en algunos ordenadores) o la velocidad de entrada de aire (en otros ordenadores) a medida que baja la temperatura exterior. Esta función es altamente recomendable para conseguir una trayectoria de aire entrante adecuada cuando la temperatura exterior es baja; y cuando la temperatura exterior aumenta, el ordenador progresivamente va reduciendo la depresión/velocidad de entrada de aire, aumentando la eficiencia de los extractores (metros cúbicos de aire por hora y por vatio consumido).

Tabla 1. Distancia teórica (en metros) que viajará el aire desde una trampilla europea, ubicada en la parte superior de la pared lateral, a lo largo de un techo liso cuando se abre 5 centímetros con una temperatura del galpón de 27 ºC (de la ecuación desarrollada por el Dr. Steven Hoff, Universidad Estatal de Iowa ).

Por lo tanto, durante una tarde de otoño, el aire que entra por una trampilla podría fácilmente llegar al centro de un galpón de 15 metros de ancho, pero por la noche, el aire entrante frío podría caer al suelo a poco más de 3 metros de distancia de la pared lateral.
El ambiente para las aves podría ser excelente por la tarde y relativamente frío por la noche con la misma abertura de entrada, depresión y mismos extractores funcionando.
Por eso es tan importante que los avicultores evalúen la trayectoria del aire entrante cuando las temperaturas exteriores son las más bajas.
Si el alcance del aire entrante es aceptable a primera hora de la mañana o en la noche, es probable que la trayectoria del aire entrante siga siendo aceptable a medida que las temperaturas exteriores aumenten durante el día.
Aunque generalmente se requieren velocidades de entrada de aire más altas a medida que bajan las temperaturas exteriores, es importante tener en cuenta de que programando mayores valores de depresión en el ordenador, puede no mejorar la trayectoria del aire entrante.
Esto se debe a que el ordenador de un galpón aumenta la depresión disminuyendo el tamaño de la abertura de entrada.

Como se puede suponer, a medida que disminuye el tamaño de la abertura de entrada, disminuye el flujo de aire de las trampillas.
Es por eso por lo que, a veces, es mejor aumentar la depresión cerrando una parte de las trampillas de el galpón (es decir, 1/4, 1/3, etc.).
Esto permitirá al avicultor aumentar la depresión sin reducir el tamaño de apertura de las trampillas.

Aunque no existe una depresión única que funcione en todos los casos, generalmente se recomienda usar una depresión entre 12 y 32 pascales (4,6 y 7,1 metros/segundo) en la mayoría de los galpones.


Programar depresiones más bajas funcionan mejor durante climas moderados a cálidos con aberturas de entrada más grandes (5 centímetros o más).
Por el contrario, depresiones más altas son más adecuadas para climas más fríos con aberturas de entrada más pequeñas (de 3 a 5 centímetros).
Determinar la depresión óptima y la apertura de entrada requerirá experimentar pruebas de ensayo y error.
Los avicultores pueden ver la trayectoria del flujo de aire entrante fijando al techo un trozo de cinta de inspección de 13 a 25 centímetros frente a una o dos trampillas cada pocos metros desde la pared lateral hasta el punto más alto del techo.
Cuando los extractores de ventilación mínima están funcionando, la cinta de inspección más cercana a la pared lateral debe posicionarse paralela al techo, mientras que la más cercana al punto más alto del techo apenas debe moverse, lo que indica que el aire se está moviendo lentamente hacia el suelo.
Dado que el circuito del aire variará con la temperatura exterior, los avicultores deben realizar observaciones a lo largo del día, prestando especial atención por la mañana temprano y en la noche, cuando las temperaturas exteriores son más bajas.
Los avicultores a menudo encontrarán que, si consiguen que el aire entrante llegue cerca del centro del galpón durante las horas más frías del día, la trayectoria del aire irá mejorando a medida que las temperaturas exteriores aumenten a lo largo del día.
Depresión, velocidad del aire y la trayectoria del aire entrante DESCÁRGALO EN PDF













Cambie al ventilador de transmisión directa EnduraMax™ para ahorrar hasta un 40 % en costos de energía.*
El ventilador de transmisión directa de Chore-Time permite controlar con máxima precisión la ventilación de su galpón con ahorro.
Totalmente compatibles con su controlador CATALYST®, los ventiladores EnduraMax™ utilizan los sensores existentes con el motor de velocidad variable para garantizar temperaturas estables para un mejor rendimiento de las aves.
El diámetro de 57 pulgadas (145 cm) facilita la actualización de los ventiladores de transmisión por correa.


Ing. Eduardo Cervantes López Consultoría Internacional - Gerencia Productiva e Innovadora en Procesamiento de Aves
¿Qué similitudes operacionales tiene este deporte con la parte final del negocio del pollo de engorde, donde se pierde o se gana la inversión en tiempo y dinero?
Este último elemento se puede recuperar. El tiempo nunca.
No soy experto en temas deportivos terrestres, pero hasta donde he podido investigar el basquetbol es el único que se juega a una ¡velocidad asombrosa!
De igual manera, el faenamiento de las aves se ha llegado a realizar hasta 16.000 pollos/hora, equivalente a 266 pollos/ minuto, o sean ¡4 pollos/ segundo!


Hay paradas estratégicas durante el partido, así como en el procesamiento.
Celebran campeonatos anuales para determinar quién es el ganador de estas contiendas.

En el negocio del pollo de engorde, cada granja se puede asociar a un campeonato y sus integrantes son los galpones.
El balón es cada ave que pasa mano a mano y debe manipularse con cuidado y firmeza para evitar que caiga.
Días antes de efectuarse el próximo partido, el entrenador y sus asistentes se reúnen con los jugadores para mostrarle videos de juegos recientes de su próximo rival.
Se hace un análisis detallado de su habitual estilo, con el propósito de diseñar un plan de acción que les permita neutralizar sus ventajas en cuanto a la forma como plantean el partido y los jugadores más habilidosos que tienen; así mismo, sus falencias características, que deben aprovecharse para ganar este partido.
En la planta antes de iniciarse el proceso diario, los responsables de la administración reúnen el personal de cada sección y se les exhorta para que durante la jornada mantengan un ritmo de trabajo constante. Objetivo: determinar quién da los mejores resultados en cada granja y luego establecer cuál obtuvo los mejores números de forma estable.
Así mismo, los que tienen resultados preocupantes. En ambos casos, se estudian los factores que influyen positiva y/o negativamente.


Sin embargo, en muchas de las plantas de procesamiento visitadas en Latinoamérica y España, no le dan mucha información sobre:
Las características, condiciones físicas y sanitarias;
Así como también, el manejo apropiado que deben recibir las aves, con el fin de obtener los resultados programados.
Ubicación de la granja – condiciones climáticas y altura sobre el nivel del mar.
Distancia y duración del viaje hasta la planta – pronóstico del tiempo.
Pesos promedios de cada uno de los tamaños que llegarán y sus respectivas edades.
¿Las aves vienen sexadas?
Presentan algunos problemas físicos que no afectan la condición sanitaria de las carcasas procesadas tales como: problemas de patas, pododermatitis, celulitis, etc.
Problemas de ayunos: insuficiente y/o prolongados.
Toda esta información es fundamental para planear los ajustes en el proceso en tiempo real que se debe llevar a cabo.
De esta manera, se podrá sostener hasta donde las circunstancias operacionales lo permitan, los parámetros de control en los aspectos de calidad, rendimiento en seco y gastos.
Tener presente como en el basquetbol, que mantener y manejar apropiadamente el balón es la decisión adecuada para quienes laboran en la planta, el ave manipulada delicadamente ayuda a alcanzar los requerimientos del proceso.
Al finalizar la jornada se analizan los resultados obtenidos, explicándole al personal los motivos por los cuales se cumplieran o no fue posible.

Este estudio práctico servirá para tomar las acciones correctivas con el fin de tenerlas en cuenta durante el faenado de las aves al día siguiente.


Al llegar a la granja la cuadrilla de recolección y los conductores de los vehículos y/o montacargas si los utilizan, el responsable de ésta, le dará entre otras la siguiente información del galpón donde se van a recolectar los animales:
Raza
Edad
Peso promedio vivo
¿Están sexados?
Nivel de uniformidad
Cantidad y densidad / metro cuadrado
Estado de la cama. ¿En qué porcentaje se encuentra seca y suelta?
¿En qué sitios se han detectado problemas de humedad? ¿por qué?
Condiciones de las aves:
Problemas de cojera
Pododermatitis
Arañazos y celulitis
Otros
Si el galpón no tiene cerramientos, recordarle la importancia de cumplir estas instrucciones para no afectar la calidad física y fisiológica de los pollos
Los recolectores deben entrar a las casetas caminando despacio – imitando a las aves-, silenciosamente.
En grupos de dos utilizando mallas o lonas ir movilizándolas hasta el área donde se capturarán para completar la cantidad aproximada que debe agruparse.
Si se ingresan los arrumes de jaulas éstos deben desplazarse sobre tubos plásticos que han sido mojados con agua para facilitar la labor del personal.
Objetivo: dividir las aves en dos grandes cerramientos, dejando un pasillo despejado en el centro de la caseta.
Si el atrape de los pollos es por las patas, sostener los animales por las mismas únicamente. No hacerlo ocasiona magulladuras. Levantarse cuidadosamente y caminar con los pollos manteniendo los brazos rectos y sin moverlos.

Propósito: evitar el aleteo intenso. Se reduce hasta un 90%.
Beneficios: disminución significativa de golpes y traumatismos en las alas, hemorragias en las pechugas por ruptura de los frágiles huesos del tórax. Eventualmente hematomas en esa zona también.
Si la recolección es por el cuerpo, mantener las alas pegadas a éste sin ejercer mucha presión para no afectar el normal funcionamiento de los sacos abdominales.
Independientemente del método de captura las aves deben ubicarse cuidadosamente dentro de las jaulas, para evitar que peleen entre sí, corriéndose el riesgo de ocasionarse laceraciones con distintos grados de severidad.
A los conductores se le debe recordar la importancia en dos situaciones especiales que se presentan en la carretera y demandan la reducción de la velocidad de crucero.
Las curvas tomarlas a una velocidad máxima de 40 kph.
Los reductores de velocidad deben pasarse con la mínima inercia que trae el vehículo para que los pollos no leviten, golpeándose la espalda y al caer la pechuga, produciéndose en ambos casos hematomas.
Estado de las jaulas: Buen estado, con tapas que deben ajustar bien.
Densidad: Acorde con el peso y las condiciones climáticas.
La movilización de los arrumes de jaulas con destino a los camiones que transportan los pollos a la planta se puede realizar manualmente utilizando sistemas de winches accionados a control remoto.
Esta última implementación disminuye la fatiga del grupo de recolectores.
Durante el desarrollo de esta etapa previa al procesamiento de los pollos, el jefe de logística, sus asistentes que algunas empresas tienen los administradores de las granjas y el galponero, deben estar evaluando ¿si las actividades se están llevando a cabo, según las instrucciones impartidas antes de iniciarse todos los días?

Si detectan algún detalle de inmediato debe conversar con el personal responsable de la dirección para tomar las medidas correctivas en tiempo real, asegurando de esta manera el logro o su cercanía de los parámetros de gestión establecidos.
Antes de iniciarse el proceso debe explicarse a las personas que laboran en cada una de las áreas dos tipos de información:
Genérica
Granja – ubicación, temperatura ambiente, altura sobre el nivel del mar.
Raza
Cantidad
Edad
¿Están sexados?
Peso Promedio vivo
Grado de Uniformidad
Problemas de Calidad:
Cojeras
Pododermatitis

Ayuno Insuficiente y/o Prolongado
Puntual para cada sección
Galpón de espera y área de recibo próxima al colgado en el transportador aéreo de sacrificio.
Ayuno Insuficiente. Se detecta durante el desangrado, desplumado y evisceración: Buche abultado por tener alimento en intestinos llenos que se alojan cerca a la cloaca.
Ayuno Prolongado. Al observar el piso de la zona donde se almacenan los arrumes de jaulas, hay materia fecal con residuos de mucosa y/o submucosa, cuyo color es rojo.
Al llegar al área de evisceración los siguientes órganos tienen estas características:
Intestinos: Presentan fragilidad por las pérdidas de las dos capas internas que han sido evacuadas.
Hígado: Color oscuro y un poco más pequeño.
Vesícula Biliar: Tejido llevado al máximo de su resistencia, ya que la bilis se ha acumulado. Por más cuidado que se tenga manual o mecánicamente se rompen muchas, derramando la bilis interna y externamente en las carcasas. Si la mancha no se lava en los siguientes 15 segundos, quedará indeleble.
Extracción de buche y Tráquea.
Dada la deshidratación producida en estos órganos, se adhieren a la cavidad corporal y el pescuezo dificultando su retiro. En caso de efectuarse manualmente aumenta el esfuerzo, anticipando la fatiga de los trabajadores.
Retiro de la Cutícula de la Molleja. Este órgano también sufre una deshidratación, aumentando la adherencia de esta película interior. Debido a la peristalsis inversa se mancha con distintos tonos de verde que caracteriza a la bilis.
Las pérdidas de la carne de este apetecido órgano son enormes encontrándose en un rango de trituración parcial hasta un 3/4 de la carne vendible.

Identificados estos problemas de ayunos los responsables del área de logística deben comunicárselo de inmediato a:
La Granja donde se recolectan las aves.
A cada una de las secciones de la planta para que estén alerta.
Basquetbol- Reglas que pueden ayudar a mejorar la productividad integral durante la prefaena y el procesamiento de los pollos
DESCÁRGALO EN PDF
Otro tema que merece especial atención es la muerte de los pollos por estrés, los cuales se identifican al momento de sacarlos de las jaulas o en las bandas transportadoras que los movilizan a granel hasta la zona de colgado. Dependiendo del clima y la altura sobre el nivel del mar, se han logrado estos asombrosos parámetros de gestión:
Ambiente caluroso y menos de 1.200 metros sobre el nivel del mar: 0,05% sobre el total de los pollos recibidos en la planta para faenamiento.

Frío y Alturas sobre el nivel del mar superiores al valor anterior: 0,03%.
Finalizando el procesamiento se estudian los resultados con el personal que participó en esta actividad, Si los valores son satisfactorios; así como también preocupantes se explicarán las causas para definir el plan de acción para el día siguiente.
En resumen, si estas dos operaciones finales en la cadena del pollo de engorde se gerencian con el criterio de la microgestión.
Es posible mantener resultados aceptables, que aseguren una calidad, rendimiento y gastos razonables, obteniéndose una rentabilidad que asegure una buena participación en este competitivo mercado de las carnes de los animales terrestres.
La industria avícola está evolucionando Tradicionalmente, el fileteado de pechugas ha sido un proceso manual y laborioso.

de obra están impulsando el cambio hacia


Al automatizar el deshuesado, es esencial mantener la flexibilidad para producir diversos productos: filetes simples o dobles, con o sin piel, con o sin solomillo, con recorte de tendón, entre otros.
Para responder a estas demandas, BAADER ofrece deshuesadoras altamente configurables para mitades delanteras o pechugas sin espalda. Ambas pueden personalizarse con diversas herramientas, permitiendo a los procesadores adaptar el equipo a sus necesidades.
Las máquinas de deshuesado de pechugas BAADER son versátiles y automáticas, diseñadas meticulosamente para preservar la calidad del filete y optimizar el rendimiento.
El nivel de automatización puede configurarse para adaptarse al fileteado semiautomático o completamente automático, ofreciendo el más alto grado de flexibilidad en la producción.

Foto1. Las Deshuesadoras de pechuga BAADER son altamente configurables, adaptándose a diversas demandas del mercado y brindando a los procesadores flexibilidad para una producción eficiente.
“Encontrar un sistema automatizado capaz de manejar variaciones de tamaño sin comprometer la calidad era clave para nosotros. En KemperKip, nuestro compromiso con la excelencia abarca toda la producción, incluida la automatización. Con la Deshuesadora de BAADER, hemos logrado mejores rendimientos, reflejados en el peso de las carcasas tras el fileteado”.
Henri Verstappen, Director General de KemperKip.
Las versiones completamente automáticas manejan sin problemas la cosecha automática de filetes y solomillos, así como la cosecha de carne sobrante y cartílago del hueso esternal.
En contraste, las versiones semiautomáticas requieren la cosecha manual de filetes y no están equipadas con herramientas para la cosecha de carne sobrante y cartílago del hueso esternal.
Foto 2. En lugar de ser descartado, el hueso esternal del pollo puede ser cosechado y utilizado en aplicaciones culinarias para agregar sabor y riqueza a los platos.

La elección entre cosecha manual o automática depende de varios factores.
Los trabajadores expertos adaptan el proceso manual a las características únicas de cada producto para garantizar la calidad y cumplir con diversas demandas del mercado.
Foto 3. El desollado automático es opcional y puede omitirse fácilmente si se desea conservar la piel en los filetes.
En cambio, la automatización emplea una estación de medición de tamaño integrada que ajusta en tiempo real las herramientas de deshuesado, mejorando eficiencia y rendimiento, ideal para quienes buscan optimizar la producción.


El deshuesado manual es intensivo en mano de obra, lo que aumenta la dependencia de trabajadores calificados y los costos, al mismo tiempo que introduce variabilidad en la asistencia y la consistencia de los trabajadores.
Se requiere formación continua para mantener una fuerza laboral calificada.
En contraste, las soluciones automatizadas solo requieren tareas básicas, como cargar productos.

La automatización reduce las tareas repetitivas, mejora la seguridad en el lugar de trabajo y ofrece espacios de trabajo ergonómicos con estaciones de carga ajustables para dos trabajadores.
Las pechugas sin espalda o mitades delanteras se transportan de manera segura a través de herramientas mecánicas para el desollado, raspado y corte en montaduras giratorias, asegurando una transición fluida en el proceso.
El nivel de automatización debe adaptarse a las necesidades de cada procesador.
Optimizar el rendimiento es clave, ya que cada gramo cuenta. Las deshuesadoras BAADER usan cuchillas diseñadas para maximizar la carne en el filete y minimizar el desperdicio.

Mientras el deshuesado manual depende de la habilidad del operador, las máquinas automáticas destacan en recuperar eficientemente la carne residual.
Foto 4. Las pechugas de pollo se cosechan con una mínima cantidad de carne residual.
Con una navegación intuitiva y cuatro recetas preestablecidas disponibles en la pantalla, la configuración de la producción se vuelve rápida y sencilla, especialmente durante los turnos de producción.
Al utilizar estas recetas, los operadores pueden seleccionar rápidamente la configuración exacta de la máquina necesaria para producir cualquier producto deseado.
Estas recetas son rápidas de configurar y se pueden modificar fácilmente siempre que sea necesario.
Esta función intuitiva no solo mejora la eficiencia, sino que también minimiza los errores humanos en la configuración de la máquina.


Foto 5. Las Deshuesadoras BAADER se controlan fácilmente desde una pantalla táctil.
Para más detalles sobre las deshuesadoras BAADER, visita nuestro sitio web o contacta a tu oficina local de BAADER: www.baader.com
Agregar valor con un deshuesado flexible de pechuga DESCÁRGALO EN PDF

BAADER se compromete a ayudar a los procesadores a mantenerse competitivos mientras responden a la creciente demanda de carne de pechuga deshuesada. Su más reciente innovación, la Deshuesadora de pechugas sin espalda 660A, es un sistema automatizado que garantiza una producción eficiente de filetes de alta calidad, operando a gran velocidad y con un mínimo de mano de obra.
/ Funciona con solo dos operadores de carga
/ Ocupa menos de 9 metros de espacio
/ Ofrece una gran variedad de productos de filete
/ Ajusta las herramientas según el tamaño individual del producto procesado
/ Funciona con recetas preestablecidas
/ Permite procesar un amplio rango de peso del producto
Equipo Técnico Cobb-Vantress
Los sistemas de anidación están diseñados para maximizar la producción de huevos limpios y estables que estén libres de contaminación y que no hayan estado expuestos a la humedad.
Desafortunadamente, un productor tendrá un lote que, de vez en cuando, rechazará los nidos y pondrá huevos fuera de ellos (en la cama o sobre los slats/rejillas).


En casos extremos, si una parte importante del lote pone fuera del nido, el rendimiento de la eclosión y la calidad de los pollitos pueden verse afectados. Además, la recolección de huevos en el suelo requiere mano de obra adicional y crea riesgos de bioseguridad en la planta de incubación.

Si bien los huevos puestos en el suelo son un problema durante el período de producción, existen prácticas de manejo durante la crianza que pueden prevenirlos.
En algunos casos, las aves no pueden acceder fácilmente a los nidos porque no aprendieron a saltar durante la crianza.
Los enriquecimientos en la crianza son una opción viable para enseñar al ave a trepar y saltar.
Elegir el tipo de percha adecuado también es muy importante. Si las aves van a ser trasladadas a un sistema de nido mecánico, elija perchas planas (no perchas tipo A), preferiblemente fabricadas con los mismos slats (perchas) que las que se encuentran en producción.
Una vez que las gallinas comienzan a poner huevos fuera del nido, es muy difícil cambiar su comportamiento.

Imagen 1. Camine entre el lote de forma lenta y tranquila durante la crianza para estimular el movimiento y la movilidad de las aves. Siga la práctica en la producción para ayudar a prevenir que las gallinas pongan huevos en la cama.
La colocación de perchas tipo slat debajo de una línea de niple también estimulará el salto y creará una asociación positiva entre saltar sobre los slats y beber. La altura de los slats no debe ser superior a 45 cm.

El tipo de alimentador también puede afectar la movilidad. Con comederos tipo plato, el ave se desplaza por debajo del comedero.
Los comederos de cadena durante la crianza estimulan la movilidad, pero deben estar colocados lo suficientemente bajos para alentar a las pollitas a saltar sobre la pista.
Cuando se utilizan comederos de plato en la crianza, se recomienda incorporar enriquecimientos. Se pueden implementar enriquecimientos en la colocación con rampas de acceso.

Imagen 2. Si se instalan comederos en los slats, asegúrese de que la altura sea la correcta para que las gallinas puedan pasar fácilmente por encima de los comederos para acceder a los nidos.
La intensidad de la luz también puede provocar futuros problemas con los huevos en el suelo. Una intensidad de luz muy baja (<1 lux) durante la crianza puede reducir la actividad de las aves.
Por lo tanto, la intensidad de la luz debe mantenerse a un nivel que permita a los trabajadores de la granja realizar sus tareas normales y sea lo suficientemente alta para promover la actividad de las aves (2 a 5 lux).

Tenga en cuenta que la intensidad de la luz durante la crianza superior a 5 lux puede afectar negativamente la fotoestimulación de las hembras.
Las gallinas necesitan sentirse seguras cuando ponen huevos y buscarán áreas relativamente oscuras para ponerlos. Es más probable que pongan huevos en lugares oscuros en lugar de en los nidos que pueden estar más lejos.
Por lo tanto, evite áreas sombreadas con iluminación uniforme y asegúrese de que no haya sombras cerca de los extremos de los slats ni luz directa sobre las cajas nido.

Imagen 3. Ácaros rojos.
Demasiadas camas en el suelo pueden animar a las gallinas a poner huevos fuera del nido. Mantenga la altura de la cama entre 4 y 6 cm según la configuración del galpón y el tipo de nido.
Las gallinas pueden agruparse alrededor de las líneas de bebederos si el acceso al agua es insuficiente y bloquear las entradas a los nidos. Los productores siempre deben seguir las instrucciones técnicas de los fabricantes y no limitar ni exceder la cantidad sugerida de bebederos por ave.
Las corrientes de aire dirigidas a la abertura del nido en lugar de al techo pueden perturbar a las aves y hacer que abandonen los nidos. Asegúrese de que todos los ajustes de ventilación y el movimiento del aire estén dirigidos en la posición correcta.
Los comederos y bebederos nunca deben impedir el acceso a las cajas nido. Cuelgue los comederos a alturas que permitan a las aves pasar por debajo de ellos o por encima de ellos colocados directamente sobre los slats. Asegúrese de que la altura de los bebederos, la cantidad de aves por niple y la


Los interiores de las cajas nido deben estar limpios y libres de parásitos. Los ectoparásitos, como los ácaros rojos, pueden molestar a las gallinas y hacer que eviten los nidos. Se recomienda retirar y lavar las almohadillas sucias, luego dejar que se sequen completamente antes de volver a usarlas.
Tener un pequeño excedente de almohadillas (alrededor del 20%) a mano permitirá reemplazar de inmediato las almohadillas sucias y evitará dejar nidos sin almohadilla.

Por lo general, una proporción de huevos en el suelo superior al 2% sugiere que hay un problema o que es necesario realizar mejoras. Recoja los huevos del suelo con regularidad para que las aves tengan la mínima posibilidad de asociarlos con la cama.
Recolecte huevos del suelo cuatro veces al día hasta que el lote tenga 27 semanas de edad. Los estándares de caminata también son útiles para disuadir a las hembras de poner huevos en las esquinas o en el suelo.
Determine si las gallinas tienen dificultades para acceder a los nidos. Si saltar parece ser un desafío, verifique la altura de los slats (debe ser de 45 cm o menos) y considere instalar rampas como una solución rápida.
Verifique la disponibilidad de agua y determine si las gallinas se están amontonando alrededor de las líneas de niples y bloqueando el acceso a los nidos.
Manejo de huevos en el suelo en reproductoras de pollos de engorde
DESCARGUE EL PDF
Asegúrese de que haya una cantidad suficiente de nidos disponibles. Dado que aproximadamente el 80% del lote pondrá huevos en el mismo período de tiempo, las cajas nido pueden quedarse llenas. Las gallinas que no pueden encontrar fácilmente un espacio tenderán a poner sus huevos en el suelo.
Es importante gestionar de forma proactiva la producción de huevos en el suelo. Entrene a las pollitas al principio de la crianza, haciendo hincapié en una buena movilidad. Asegúrese de que las cajas nido en producción sean atractivas y de fácil acceso.
Si se ponen huevos en el suelo, la ubicación y el momento pueden proporcionar pistas sobre por qué la gallina eligió ponerlos en el suelo en lugar de en los nidos.
Una buena observación y la adopción de medidas ante la primera señal de producción de huevos en el suelo pueden ayudar a mitigar el problema al inicio de la producción.

Renata Steffen Hatchery & Incubation Specialist.

Con la evolución genética, el pollo de engorde reduce el tiempo de crianza en el campo, alcanzando el peso de sacrificio antes.
A mediados de 2010, el pollo llegaba a un peso de 2,5 kg con 42 días.
Mientras en el 2020, el pollo llega a este mismo peso con 36 días.

Pero el tiempo de desarrollo embrionario no ha cambiado, 21 días para desarrollar y nacer, siendo que el porcentaje de su vida en la planta de incubación aumentó debido a su mejor eficiencia en el campo (Gráfico 1).

Incubación Producción
Gráfico 1. Participación de la incubación en la vida de un pollo de 2,5kg. Fuente: COBB.

Uno de los puntos claves para la calidad del pollito es la ventana de nacimiento que tiene como concepto el intervalo entre el primer y el último pollito nacido.
Pero en la práctica es muy difícil saber este intervalo tan preciso de nacimiento.
De forma más didáctica y práctica la ventana de nacimiento se calcula sobre el porcentaje de pollitos nacidos x horas de incubación, estableciendo así una curva de pollitos nacidos.

Las plantas incubadoras buscan la excelencia en calidad del pollito, que puede sufrir gran interferencia en el transcurso de la propia ventana de eclosión, y sumado al tiempo gastado en el manejo de los pollitos (sexaje, vacunación, expedición y transporte), puede someterlos al ayuno de hasta 72 horas hasta la llegada al galpón de alojamiento con el productor.
Este largo tiempo del nacimiento al alojamiento puede causar deshidratación, deficiencia en la absorción del saco vitelino y daños al desarrollo intestinal que debilitan a los pollitos, lo que puede aumentar la tasa de mortalidad en la primera semana de vida y disminución del peso a los siete días.
Cuanto mayor sea la amplitud de la ventana de eclosión, más largo es el período de ayuno al que se someten los primeros pollitos nacidos, y juntos tendremos pollitos demasiado hinchados, ya que estos nacieron muy cerca de la retirada y no tuvieron tiempo necesario para realizar la pérdida de humedad necesaria después del nacimiento.

La Figura 1 representa:
Una ventana de nacimiento más uniforme (línea azul), menor tiempo de eclosión entre los primeros y últimos nacidos con una gran concentración de pollitos naciendo al mismo tiempo.
Una ventana de nacimiento más abierta (línea amarilla) gran diferencia de tiempo entre los primeros y últimos pollitos nacidos y no se observa una concentración de pollitos naciendo en el mismo intervalo.

Tiempo
Ventana de nacimiento Recogida de pollitos de la nacedora
1.

Para tener una ventana de nacimiento adecuada los cuidados comienzan incluso antes de la incubación:
Calidad y uniformidad de los huevos.
Gestión del almacenamiento de huevos.
Gestión de la incubación, con carga correcta dentro de las incubadoras.

Gestión correcta del desarrollo embrionario.
Estos 4 puntos de gestión son muy importantes para la calidad de los pollitos y además de ser fundamentales en el control de la ventana de nacimiento tienen correlación con el tiempo de incubación total de los pollitos.
Un punto muy importante es diferenciar el tiempo de la ventana de nacimiento del tiempo total de incubación para la retirada de los pollitos de las nacedoras.
Las horas totales de nacimiento o de retirada de los pollitos de la nacedora se cuentan desde la hora de incubación hasta la retirada de los pollitos listos y estas horas variarán según cada planta de incubación, línea que puede ser de 504 a 516 horas.
Al final de estas horas el pollito es retirado de la nacedora y procesado para ser enviado a la granja.
En la Tabla 1 de abajo tenemos algunos indicadores que pueden influir en la ventana de nacimiento y/o horario recogida del pollito.
Indicador
1. Incubación demasiado temprano o demasiado tarde
2. Temperaturas incorrectas de incubadoras y nacedoras
Influencia en la ventana de nacimiento
3. Sin precalentamiento ++
4. Días de almacenamiento de huevos
5. Edad de las reproductoras
Influencia en el horario de retirada de los pollos nacedora
6. Microclima de las incubadoras y nacidos +++ +
1. Indicadores que pueden influir en la ventana de nacimiento.
Incubación demasiado temprano o demasiado tarde
Cuando hablamos de incubación debemos tener en cuenta el total de horas incubadas, que se refiere al horario desde inicio de la incubación hasta la retirada de los pollitos de la nacedora.
Este indicador está extremadamente relacionado con las horas de incubación, pues diferentes linajes tienen diferentes horarios de incubación y también los días de almacenamiento de huevos interfieren en las horas de incubación.

Ejemplos: Cuando tenemos almacenamiento de 6 o más días tiende a haber un aumento en el horario de incubación de 0,5 hs a 1 hs por día a más de almacenamiento, ya que tenemos embriones embrionarios más lentos que necesitan más horas de incubación cuanto más días de almacenamiento tenga.
Otro factor que interfiere en las horas de incubación son las estaciones del año.
En invierno, debido a las bajas temperaturas los huevos alcanzan la temperatura de 23ºC más rápido que en verano, y ellos tienden a tener menor desarrollo de número de células embrionarias.
En verano tenemos más células embrionarias y con eso menos horas de incubación que en invierno por tener un embrión más desarrollado a la hora de la incubación.
Temperaturas incorrectas de incubadoras y nacedoras
La temperatura de desarrollo embrionario es un factor muy importante para la calidad de los pollitos y va a interferir tanto en la ventana como en el horario de retirada de los pollitos de las nacedoras.

Con altas temperaturas durante el desarrollo hay una aceleración de los embriones, haciendo que adelante su nacimiento.
Podemos notar este problema cuando hay un alto índice de huevos picudos en la transferencia, entre 18 y 19 días de incubación y pueden encontrarse pollitos nacidos dentro de la máquina incubadora.
Lo ideal es que no haya huevos picoteados en la transferencia o que sea inferior al 2%.
Solución de datos segura basada en la nube


Conecte su planta de incubación con el mundo de los macrodatos
El software de incubación inteligente que convierte los datos en el máximo rendimiento avícola
Las plantas de incubación tienen una gran cantidad de datos valiosos. Desbloquear el potencial de esos datos es una gran oportunidad para mejorar el rendimiento general de las plantas de incubación y de toda la cadena de valor. Con Eagle Trax™, Petersime ofrece el primer software de incubación inteligente que convierte los datos en el máximo rendimiento avícola. Eagle Trax™ le permite digitalizar, analizar y utilizar de manera óptima los datos para incrementar cada vez más la eficiencia, la productividad y la calidad de los pollitos de la planta de incubación.
Con Eagle Trax™, su planta de incubación siempre maximizará el potencial genético de cada huevo fértil y ofrecerá una producción predecible y más rentable de los pollitos de un día para todos los implicados en la cadena de valor avícola.
Escanee para obtener más información:
% de pollitos
En el gráfico A tenemos un ejemplo de una incubadora con temperatura uniforme, pero elevada para los embriones a los 18 días, media de temperatura de 102ºF (38,9ºC).
Gráfico A. Temperatura con 18 días de desarrollo embrionario - temperatura más alta que la ideal 37,8 ºC - media de - 37,5 ºC .
Horas de incubación
Gráfico A1. Modelo de ventana de nacimiento para embriones en desarrollo a una temperatura más alta durante todo el período de incubación.
En el Gráfico A1: la ventana de nacimiento en este caso será una ventana en la que el 80% de los pollitos nacieron entre 468 hs a 492 hs (24 hs de intervalo).
Sin embargo, la mayoría de los pollitos nacieron 32 hs antes de la hora de salida de la nacedora.
En este caso podemos encontrar pollitos ya en inicio de proceso de deshidratación, menor rendimiento de peso de pollito, con menor vivacidad al llegar a la granja.
Cuando hay un problema de desarrollo en temperatura inferior a 37,8ºC hay un crecimiento más lento del embrión y en la transferencia a los 19 días su edad fisiológica va a estar más atrasada en relación a la cronológica.

En el Gráfico B observamos en el área mayor en azul una temperatura media de embriones de 37,5 ºC y sin embargo uniforme dentro de la máquina.
Centro 2 Superior 1 2 3 4 5 6 7 8
Centro 1
102,5-103 102-102,5 101,5-102
101-101,5 100,5-101
100-100,5 99,5-100
Inferior
Gráfico B. Temperatura con 18 días de desarrollo embrionario - temperatura más baja que la ideal 37,8 ºC - con una media de 37,5º.
En el Gráfico B1 la ventana de nacimiento tiene la mayoría de los pollitos nacidos entre 484 hasta 508 (24 hs de intervalo),
sin embargo el pico de nacimiento ocurrió 12 horas antes de completar las 512 horas de incubación.
En este caso a la hora de la retirada de los pollitos éstos todavía van a estar bastante húmedos, pollitos hinchados (con alto rendimiento de humedad).
En este caso tenemos mayor porcentaje de pollitos eliminados en la clasificación, pollitos con baja vivacidad.
Gráfico B1. Modelo de ventana de nacimiento para embriones que se estaban desarrollando a una temperatura más baja durante todo el período de incubación. % de pollitos eclosionados

Horas de incubación
El precalentamiento es un factor muy importante para recomenzar el desarrollo embrionario. El precalentamiento permite calentar todos los huevos de manera uniforme y reanudar el desarrollo embrionario uniforme.
Cuando no se realiza el precalentamiento o se hace parcialmente en la carga de huevos que se va a incubar, hay consecuencias en los huevos que van a ser incubados por haber una desuniformidad de temperatura entre ellos.
En las incubadoras de etapas múltiple los huevos sin precalentamiento entran en la incubadora en un promedio de 21ºC y son colocados en la incubadora donde los otros huevos ya están a una temperatura muy cercana a 37,8ºC.

La gestión de los días de inventario de huevos es muy importante dentro de la sala de incubación para que no se mezcle entre las fechas de producción de los huevos y quedarse la carga de huevos de stock más grandes en la sala y ser incubados huevos de puesta más jóvenes.

Estos embriones más calientes pierden temperatura para el medio, como una ayuda para calentar la carga de huevos que entró, teniendo una desaceleración en su desarrollo.
En la operación de carga es fundamental siempre comenzar de la mayor fecha de puesta para la menor, para que se tenga como máximo 3 fechas de producción dentro de una misma incubadora.
Un punto importante es hacer una carga de incubación entre el mismo linaje y la misma edad entre las reproductoras o edad muy próximas.
Ejemplo; si incuba huevos procedentes de dos granjas, preferiblemente que la edad de los reproductores de los huevos incubados no sea superior a 5 semanas de vida, dentro de la misma incubadora.
La calidad de la cáscara está asociada a la edad de la reproductora y a medida que envejece hay un aumento en el peso de los huevos, menor tasa de fertilidad, mayor mortalidad embrionaria y consecuente caída de la eclosión.
Esto se debe a que las aves más viejas producen huevos con cáscara más fina y con poros de mayor diámetro, mayor relación de masa entre yema y clara.
Estos cambios en la calidad de la cáscara interfieren directamente en los intercambios gaseosos de humedad entre el embrión y el ambiente de la incubadora, que constituye un factor importante en el proceso de incubación porque afecta directamente al peso, tiempo de incubación y la calidad del pollito al nacer.
Un punto muy importante es monitorear la temperatura de los embriones dentro de la incubadora, para ver cómo está la uniformidad de la temperatura.
Cuanto más uniforme sea la temperatura de desarrollo embrionario, más uniforme será la ventana de nacimiento entre los pollitos.
Veamos algunos ejemplos de gráficos de temperatura de cáscara de embriones con 18 días de desarrollo.
En el Gráfico C de temperatura, observamos que hay una desuniformidad en la temperatura de desarrollo de los embriones dentro de la incubadora, que llamamos isla de calor - embriones más al fondo de la incubadora están más calientes (coloración roja media 39,2 ºC y los embriones situados en la parte delantera de la máquina están en un promedio de 38,5 ºC .
Esto nos muestra una gran isla de calor que interferirá directamente con la ventana de nacimiento y la calidad de los pollitos.
Los pollitos ubicados en el fondo van a estar eclosionando primero que los pollitos localizados en frente de la incubadora.
Superior
Centro 1
Centro 2
102,5-103
102-102,5
101,5-102
101-101,5
100,5-101
100-100,5
99,5-100
Inferior
1 2 3 4 5 6 7 8
Gráfico C. Temperatura de cáscara de los embriones con 18 días de desarrollo dentro de una incubadora.
Una tendencia de curva de ventana bien abierta teniendo al final pollito bien nacido iniciando un proceso de deshidratación. Los pollitos húmedos nacen más tarde cerca del horario de retirada de los mismos de la nacedora, conforme Gráfico C1.
% de pollitos eclosionados
Horas de incubación
Gráfico C1. Ventana de nacimiento del gráfico C con islas de calor dentro de la incubadora.
La ventana de nacimiento siempre será un desafío para todas las plantas de incubación, por envolver muchas variables de la granja a la incubación.
Tenemos que conocer cada variable y cómo intentar minimizar o sincronizar estas, para que ellas en conjunto tengan como resultado pollitos de alta excelencia para el cliente y éstos puedan demostrar toda su capacidad.

Desafíos para el mantenimiento de la ventana de nacimiento DESCÁRGALO EN PDF











Vinício dos Santos Cardoso y Tatiana Carlesso dos Santos Universidade Estadual de Maringá

El uso de minerales orgánicos como el cobre ha despertado un gran interés en la producción de gallinas ponedoras, ya que es esencial para la formación de huevos y huesos, para la integridad estructural de los tejidos, para la protección contra la oxidación y para el desarrollo de la respuesta inmune.
El cobre (Cu) es un oligoelemento esencial para los seres vivos en pequeñas cantidades, generalmente en escala de miligramo o microgramo.
Las principales funciones incluyen ser cofactor en enzimas involucradas en la producción de energía celular (citocromo-C-oxidasa), en la desintoxicación de radicales libres (superóxido dismutasa de cobrezinc o SOD), en la formación de tejido conectivo (a través de la lisil oxidasa), en la movilización de hierro (a través de la ceruloplasmina) y en la neurotransmisión (mediada por la dopamina β-hidroxilasa) (SUTTLE, 2010)
El cobre ha sido estudiado desde hace mucho tiempo y su característica de ser un micromineral esencial para el metabolismo fue citada en 1928 por Hart y Elvehjem, quienes al realizar algunos estudios con ratas, encontraron que el cobre es esencial para el crecimiento, la formación de hemoglobina, así como como en la prevención de una variedad de trastornos clínicos y patológicos relacionados con su deficiencia, como la anemia (McDonald, 2006).

Por lo tanto, la suplementación de cobre en las dietas es necesaria, ya que los ingredientes de origen vegetal utilizados en la elaboración de alimentos balanceados para aves en general, a pesar de tener altas concentraciones, tienen baja disponibilidad.
De este modo, es importante cubrir los requerimientos nutricionales, para que no haya exceso ni falta de este nutriente en las dietas, ya que niveles muy superiores a los requeridos pueden producir toxicidad y niveles inferiores resultan en deficiencia, comprometiendo ambas situaciones el rendimiento.

La toxicidad por cobre en las gallinas puede provocar diarrea, pérdida de peso, letargo y, en casos graves, la muerte. También puede haber cambios en el color de las heces, daños en el hígado y los riñones y una disminución en la producción y la calidad de los huevos.
La deficiencia de cobre puede causar anemia, disminución de la tasa de puesta de huevos y de la calidad de la cáscara, baja tasa de crecimiento y menor peso corporal, alteraciones en la estructura y función de los riñones y el hígado, y cambios en la pigmentación de las plumas (Schlegel, 2017).

Satisfacer los requerimientos de cobre de las aves asegura el mantenimiento de la homeostasis, el equilibrio fisiológico del animal, mejora la reproducción, el crecimiento, el desarrollo del tejido conectivo y la pigmentación de la piel (OLIVEIRA, 2019).
Para las gallinas ponedoras Hy-line W36, el requerimiento de cobre proveniente de fuentes inorgánicas en las fases de cría y recría es de 15 mg por kg y de 8 mg por kg en la fase de producción (Guia de manejo – Hy-Line 2020). Sin embargo, según Rostagno et al. (2024) afirman que para las gallinas ponedoras ligeras en general, el requerimiento de cobre proveniente de fuentes inorgánicas en las fases de cría y recría es de 9,48 mg por kg y de 10,43 mg por kg en la fase de producción (Rostagno et al., 2024).
de las gallinas ponedoras se puede realizar a través de fuentes inorgánicas y orgánicas.
Los microminerales inorgánicos existen en su forma elemental o en formas simples, como las sales inorgánicas. Estos minerales no contienen carbono y normalmente se añaden en forma de sales.

Ejemplos comunes de fuentes de este mineral traza inorgánico son el sulfato de cobre (CuSO₄), el cloruro de cobre (CuCl₂), el óxido de cobre (CuO), el carbonato de cobre (CuCO₃) y el citrato de cobre (Cu(C₆H₅O₇)₂).
Aunque las fuentes inorgánicas son ampliamente utilizadas, presentan desventajas como: factores que pueden afectar la absorción, reducir su eficiencia de uso, mayor excreción al medio ambiente, entre otros.
La otra manera de suplementación es en forma de microminerales orgánicos. El mineral orgánico es una forma diferente, donde el mineral inorgánico esencial está unido (quelado) a una molécula orgánica.
La unión da como resultado un complejo estable donde el mineral está protegido por la molécula orgánica durante la digestión y la absorción en el tracto gastrointestinal.
Esto aumenta la biodisponibilidad del mineral, es decir, mejora la capacidad del organismo para absorber y utilizar el mineral de forma más eficiente.
La unión orgánica se puede realizar con aminoácidos (glicina, lisina, metionina), proteínas (caseína), levaduras (Saccharomyces

La sustitución de minerales inorgánicos por minerales orgánicos es cada vez más común en la preparación de suplementos para gallinas ponedoras debido a sus beneficios, que son:
La quelación mejora la biodisponibilidad de los minerales, permitiendo una absorción más e ciente en el tracto gastrointestinal, lo que signi ca que la Mejor absorción:


Reducir el riesgo de toxicidad:

La quelación puede reducir el potencial de toxicidad mineral al ayudar a controlar la liberación y absorción

Estabilidad y seguridad:
Los complejos quelados son más estables y tienen menos probabilidades de degradarse o precipitarse
Menor irritación gastrointestinal:
probabilidades de causar irritación en el estómago y

El interés en utilizar cobre orgánico en dietas para animales de producción, especialmente en aves de corral, se debe a que el cobre inorgánico no está o se vuelve no disponible para la absorción porque es secuestrado por compuestos como el fitato, así como por la competencia entre microminerales por algunos transportadores.
Debido a las ventajas de la quelación, al trabajar con cobre orgánico para gallinas ponedoras, es posible suplementar en cantidades menores a las establecidas en los requerimientos, sin comprometer el rendimiento y la calidad de los huevos.
Los estudios demuestran que esta suplementación de cobre orgánico proporciona efectos positivos para las gallinas ponedoras comerciales y reproductoras de pollos de engorde, siendo los principales:
Los principales efectos son: mejora del rendimiento y resistencia de la cáscara, calidad interna y externa del huevo, reducción de la excreción al medio ambiente, aumento de la capacidad antioxidante y modulación de genes implicados en la formación de la matriz orgánica en la glándula de la cáscara (Passos, 2010; Dong, et al., 2022; Qiu y col., 2020; Yaqoob, et al., 2020);
En reproductoras pesadas durante el período pico de postura, se observó una mejora en la calidad del huevo y en el estado antioxidante hepático (Yaqoob 2020);
En las gallinas ponedoras comerciales al final de la producción, hubo un aumento en el espesor y la resistencia de la cáscara, una mejora en la ultraestructura de la cáscara y un aumento de la deposición de minerales en la cáscara, un aumento de la capacidad antioxidante y la función inmune y una disminución de la excreción de minerales en las heces (Zhang 2021).
Formación ósea, debido a que este oligoelemento es un activador de la lisil oxidasa, enzima que participa en la biosíntesis de colágeno (POPHAL e SUIDA, 2007).

Por lo tanto, el uso de cobre orgánico es una estrategia nutricional interesante en la alimentación de gallinas ponedoras, ya que su aplicación mejora los índices de producción sin comprometer el rendimiento y la calidad de los huevos, además de una menor excreción del elemento al medio ambiente.
El cobre y sus funciones en la dieta de las gallinas ponedoras: Ventajas de la forma quelada DESCÁRGALO EN PDF

Equipo Técnico H&N

En esta segunda parte del artículo “Bioseguridad en tiempos de Influenza Aviar” trataremos la lista de medidas de bioseguridad de especial importancia en los periodos de riesgo de aparición de casos de Influenza Aviar.
Los programas de bioseguridad deben estar armados para evitar el riesgo de introducción de la enfermedad con anterioridad a los períodos de alto riesgo de Influenza Aviar. En cualquier caso, durante estos periodos existen una serie de medidas que son especialmente críticas y deben ser reforzadas.


Evitar contacto con las aves silvestres
Debe evitarse cualquier contacto directo con estas aves y las aves de corral. debe asegurarse que los galpones son “a prueba de aves silvestres”. Esto implica:
Paredes y techos de la granja deben de ser estancos y no permitir el acceso de ningún tipo de ave silvestre

amigables” para aves silvestres. Para ello:
Impedir la aparición de zonas de agua estancada.
La puerta de paso debe permanecer cerrada cuando no estén en uso y no deben de dar acceso directo a la zona de las aves. Las puertas que no sean de uso diario deben estar cerradas.

Las ventanas y entradas de aire deben están protegidas con malla pajarera o sistema equivalente. Debe asegurarse que esta ajusta bien y no deja espacios que den acceso a las aves silvestres.
En el caso de aves en sistemas con accesos a parques exteriores, debe pedirse autorización de los Servicios Veterinarios O ciales para que se exima de la obligación del uso de estos parques donde el contacto con aves silvestres sea imposible de controlar.
Se debe nivelar el terreno de las zonas aledañas para evitar que la aparición de estancamientos de agua.
Debe considerarse la posibilidad de utilizar desagües para drenar del perímetro de los galpones.
Evitar la anidación de aves en los galpones de la granja o estructuras aledañas. No es aconsejable tener árboles o zonas de maleza en el área circundante.
Asegurar la estanqueidad de los silos de manera que las aves no puedan tener acceso al alimento.
Igualmente, no deben permitirse los derrames de alimento que sirvan para atraer a las aves.
Evitar acopios de gallinaza en las zonas aledañas a los galpones. Siempre contiene granos de cereal no digeridos y esto atrae diversos tipos de aves.

En sistema de aves camperas, evitar tener bebederos o comederos en zonas no cubiertas en los parques exteriores.
Debe evitarse introducir material fecal infectado al interior de los galpones. Para ello:
Establecer un único punto de entrada a los galpones con un lavamanos y separación zona sucia / zona limpia con cambio a zapatos/calzas de interior. Los trabajadores ( o las visitas) nunca deben pisar el interior de la zona limpia con los zapatos usados en el exterior.

Eliminar los salientes o superficies horizontales innecesarios que puedan ser utilizados como perchas por las aves silvestres.
Adicionalmente se pueden utilizar sistemas para espantar a las aves como cañones de láser u otros dispositivos.
Debe evitarse la construcción de granjas en las inmediaciones de marismas, lagos u otras áreas donde las aves migratorias suelen hacer sus paradas.
Establecer una zona perimetral con caminos de nidos entre los distintos galpones e instalaciones de la granja. Los trabajadores sólo deben desplazarse por estos caminos marcados en su actividad diaria. Adicionalmente, se puede aplicar cal para higienizarlos.
Controlar la población de roedores ya que estos pueden actuar también como vectores mecánicos de material infeccioso.
Evitar completamente el acceso a la zona de aves de cualquier otro tipo de animal doméstico o no doméstico como
Debe asegurar un aprovisionamiento de agua libre de IA. Para ello:
Privilegiar las fuentes de captación profunda sobre las de captación de aguas de superficie.
Tratar con un agente higienizante toda el agua usada en la explotación.
Evitar que el agua de lluvia entre en el interior del galpon por el techo o por las bajeras de las puertas.



Debe asegurarse que la totalidad de la plantilla comprende el riesgo existente y que adecua su manera de trabajar y sus actividades personales a la situación sobrevenida. Para ello:
Tener lista ropa exclusiva de granja para los trabajadores. Idealmente debe limpiarse en la propia instalación y no deben colgarse para su secado en exteriores.
La posibilidad de ducharse antes de acceder a la zona de aves está fuertemente recomendada.
Los trabajadores deben tener prohibido tener aves de ningún tipo en sus casas. Especialmente aves de traspatio de cualquier tipo.


No es recomendable que los trabajadores compaginen trabajos de granja con actividades de campo, especialmente si se desarrollan en lugares donde pueden tener contacto con aves migratorias o sus deyecciones.
En caso de que los trabajadores encuentren aves muertas, no deben tener contacto en ningún caso con ellas.
Deben tener prohibido cualquier tipo de actividad que tenga relación con aves ya sea cetrería, caza, avistamiento de aves, peleas de gallos u otras similares.
Simplemente deben noti carlo a quien corresponda dependiendo de si el hallazgo es en la granja o durante su tiempo libre.

La entrada a las granjas debe hacerse con ropa y calzado exclusivo de la granja.
Si esto no fuera posible, al menos, deben proveerse a las visitas de monos desechables y de calzas y tanto la ropa como el calzado del visitante deber haberse lavado antes de la visita y tras la última visita a granja.
El uso de duchas está altamente recomendado.


Evitar la introducción de IA mediante equipamiento o material de granja
El material de granja puede estar contaminado con heces u otros fómites que permitan la supervivencia del virus y por tanto actuar como vector de la enfermedad. Para ello, para evitar este riesgo deben tomarse las siguientes medidas:
Tener en granja la mayor parte de las herramientas y equipo necesario para el correcto funcionamiento de esta.
De esta manera se evitará el tener que compartirlas con otras granjas.
Prohibir de manera taxativa la entrada a la granja de cualquier material con origen de zonas donde se hayan reportado casos de Influenza Aviar.
Si es absolutamente necesario entrar nuevo material o herramientas, estas deben ser de primer uso y no provenir de otra granja.
Si esa alternativa es absolutamente imposible y las herramientas o material han sido usados previamente, deben llegar limpiados y desinfectados de origen.
En caso contrario no deben ser aceptados. Antes de introducirlas a la granja deben seguir igualmente un proceso de limpieza y desinfección.
En cualquier caso, debe tenerse en cuenta que existen materiales (como los cartones de huevos) que son de muy difícil desinfección y por tanto nunca deben de recircular entre granjas.



Los vehículos, y en particular sus neumáticos, pueden transportar partículas de fómites que transmitan el IA. Dado que el transporte de materiales desde y hacia las granjas forma parte de la actividad de estas, es necesario tomar los siguientes puntos:

Ningún vehículo que haya circulado por zonas donde se hayan dado casos de Influenza Aviar ( y aún menos que hayan entrado en granjas infectadas) debe hacer viajes con destino a la granja.
Esto puede implicar que los vehículos tengan que seguir rutas alternativas a las habituales para evitar dichas zonas.
Establecer circuitos preestablecidos y marcados para el flujo de camiones . Idealmente estos circuitos no deben de entrar en el interior del perímetro de la granja privilegiando las descarga o recogidas desde el exterior de la granja.
Si un vehículo debe obligatoriamente entrar en el interior de la granja, debe de limpiarse y desinfectarse previamente a su llegada a la granja y tras la última visita a cualquier otra granja.
Igualmente, a su llegada debe volver a limpiarse y desinfectarse con especial cuidado a los neumáticos. Es crítico renovar la solución desinfectante periódicamente para garantizar su efectividad.
Limitar el tránsito de vehículos a la granja a lo estrictamente indispensable. Intentar igualmente disminuir el número de viajes a la granja optimizando las entregas y recogidas. Deben evitarse rutas en las que se visitan diferentes granjas.

Los camiones de retirada de cadáveres no deben entrar en ningún caso a la granja. La recogida de cadáveres debe hacerse en un punto exterior y lo más alejado posible de la granja. En ningún caso puede haber ningún tipo de contacto directo entre el personal de la granja y los chóferes de los camiones de recogida de cadáveres.

Todos los vehículos que no requieran entrar en la granja deben quedar aparcados en un parking externo a la misma. Esto debería limitar la entrada solo a los camiones de alimento, recogida de huevos y transporte de animales.
Igualmente cabe destacar que los arcos de desinfección son de gran ayuda para este trabajo, pero debe comprobarse individualmente que la desinfección de cada camión se hace de manera correcta.
Debe prestarse especial atención a la limpieza y desinfección de aquellos camiones que transporten gallinaza.
Los chóferes de los camiones deben intentar tener el mínimo contacto con el personal de la granja. Igualmente deben usar, al menos, monos y calzas durante la descarga y en ningún caso acceder a la zona de las aves.

Obviamente, debe respetarse la legislación en cuanto a movimiento de aves de corral. Adicionalmente deben considerarse las siguientes medidas:
No deben trasladarse aves desde zonas o granjas con brotes de Influenza Aviar aunque su traslado haya sido autorizado previamente y su transporte está ya organizado.
En este punto, debe respetarse el principio de precaución y actuar con el mayor celo posible.
Debe prestarse especial atención a la limpieza y desinfección de los camiones y jaulas de los transportes de aves. Igualmente debe planificar su ruta evitando zonas donde haya granjas infectadas.
No debe introducirse en la granja, en ningún caso y bajo ningún pretexto, ningún ave de corral u otro tipo, fuera de los controles oficiales.
Adicionalmente, debe considerarse la presencia de más de una especie de ave de corral en la granja como un factor de riesgo.
El viento puede vehicular plumas o partículas de polvo con cargas infectivas de IA de una granja a otra.
Es por ello por lo que debe privilegiarse la construcción de nuevas granjas en zonas lo más aisladas posibles.
Puede constatarse que esta lista de medidas es extensa, complicada y costosa de implementar, concerniente a la mayoría de los actores del sector y, con seguridad, incompleta
Como consecuencia, una bioseguridad en granjas sólo puede hacerse real y efectiva si hay un compromiso inequívoco por parte del sector en su conjunto para su implantación.

No se debe olvidar que, debido a la capacidad de mutación del IA y que su introducción en el territorio depende principalmente de su recirculación en las aves migratorias, es muy difícil prever en qué nivel de desafío se deberá afrontar en los años venideros.
Por ello, la implementación de programas de bioseguridad completos y bien adaptados a la realidad de cada granja es fundamental para poder asegurar cierta tranquilidad en nuestras operaciones.


José Francisco Miranda Jr.
Gerente de Servicios de Precisión Contenido de dsm-firmenich

La producción avícola moderna se enfrenta a constantes desafíos relacionados con la salud, la nutrición y el rendimiento de las aves.
Pequeños desequilibrios pueden tener importantes consecuencias productivas y financieras, poniendo en peligro la eficiencia y la rentabilidad de los productores. En un sector en el que el margen de error es reducido, contar con herramientas avanzadas de supervisión es esencial.
En este contexto surge Verax™, un innovador sistema basado en biomarcadores sanguíneos, capaz de proporcionar diagnósticos tempranos y precisos, permitiendo a los productores tomar decisiones basadas en datos sólidos y en tiempo real.

Verax™ es la primera herramienta del mundo que utiliza biomarcadores sanguíneos como sistema de alerta temprana para tomar decisiones críticas en la producción avícola.
Mediante el análisis de una serie de biomarcadores, como carotenoides, creatina quinasa, ácido úrico y proteínas plasmáticas, el sistema permite detectar deficiencias nutricionales, enfermedades y desafíos inmunológicos días antes de que aparezcan signos clínicos visibles.
Con este enfoque, es posible actuar de forma proactiva, reduciendo las pérdidas y optimizando la eficiencia de la producción, en lugar de depender únicamente de la observación visual o de necropsias tardías.
El análisis de biomarcadores específicos permite identificar patologías como la coccidiosis, la enteritis necrótica y los trastornos esqueléticos antes de que comprometan a todo el lote.
Los estudios demuestran que la presencia de coccidiosis puede detectarse diez días antes de que aparezcan los signos clínicos, lo que permite realizar intervenciones estratégicas para contener su proliferación.
Verax™ permite analizar nutrientes críticos como el calcio, el fósforo y la vitamina D, ayudando a evitar carencias y excesos que podrían perjudicar la absorción de nutrientes.
Uno de los casos más comunes en avicultura es la relación entre el calcio y el fósforo, donde un desequilibrio puede provocar deficiencias óseas y una mala conversión alimenticia. Con datos precisos, los especialistas pueden ajustar rápidamente la formulación de la dieta para mantener niveles óptimos de cada elemento.
El sistema también permite evaluar el impacto del estrés en los lotes. Los cambios en biomarcadores como la glucosa y la hemoglobina indican situaciones de estrés causadas por una alta densidad de población, un manejo inadecuado o el transporte.
Con esta información, los productores pueden ajustar las condiciones ambientales y la gestión para reducir la mortalidad y mejorar el rendimiento zootécnico.
El impacto de Verax™ ya se ha demostrado en varios estudios de campo. En un caso reciente, un complejo avícola se enfrentaba a altas tasas de mortalidad sin causa aparente.
Mediante el análisis de biomarcadores, se identificó que los niveles de glucosa y hemoglobina eran elevados, lo que indicaba altos niveles de estrés debido a la reducción del tiempo de descanso entre lotes.
A partir de este diagnóstico, se aplicaron medidas correctivas que dieron como resultado una reducción significativa de la mortalidad y una ganancia de 242.600 dólares al año.
En otro estudio, las aves tenían una alta incidencia de pododermatitis debido al exceso de humedad en el ambiente.
Verax™ identificó un desequilibrio ácido-base, revelando altos niveles de cloro en la sangre. La reducción de la cantidad de este elemento en la dieta mejoró la calidad de las patas en un 20%, generando un aumento de los ingresos de 39.000 dólares semanales.
Más que una herramienta de diagnóstico, esta tecnología representa el futuro de la producción animal de precisión. Al integrar inteligencia artificial y machine learning, el sistema evoluciona constantemente, generando una base de datos robusta que permite previsiones cada vez más asertivas.
Además, su aplicación se está extendiendo a otras especies, como cerdos, ponedoras y reproductoras, ampliando aún más su impacto en la cadena de producción.
Con esta innovadora tecnología, productores, veterinarios y nutricionistas tienen en sus manos un poderoso aliado para optimizar la productividad, reducir las pérdidas y garantizar la sostenibilidad de la producción animal. Verax™ no solo se anticipa a los problemas, sino que ofrece soluciones concretas para un sector que requiere eficiencia, seguridad y rentabilidad.

Ya se trate de reducir los costos de alimentación, mejorar la salud de las aves o aumentar la previsibilidad de los resultados, Verax™ es la clave para una gestión más inteligente y rentable. Al fin y al cabo, conocer a fondo a sus aves es la mejor estrategia para alcanzar un futuro exitoso en la avicultura.
Detección temprana de deficiencias nutricionales y enfermedades
DESCÁRGALO EN PDF




Cuente con un sistema de monitoreo con biomarcadores sanguíneos para ayudarle a predecir con precisión estos desafíos.

Verax™, la solución que necesitas:
Optimización de la nutrición basada en los datos generados a partir de su producción; Mejora de la salud y el rendimiento para una producción más sostenible.
Proteja sus aves, con confianza.

Descubra más dsm.com/anh/es/species/poultry




Cecilia Rosario Cortés
Facultad de Medicina Veterinaria y Zootecnia, UNAM

Escherichia coli ha sido subestimado por largo tiempo, tradicionalmente se ha considerado como un agente ambiental y oportunista en animales inmunodeprimidos, o complicante en infecciones virales en aves.
Sin embargo, desde hace algunos años, se le considera ya como un patógeno primario que causa pérdidas multimillonarias a nivel mundial, aunque a ciencia cierta es difícil calcular su impacto real.
El impacto económico se ha relacionado a una disminución del crecimiento y decomisos en la planta de procesamiento en pollo de engorde, baja producción en gallinas de postura, así como un incremento en la mortalidad. Incluso, cuando las condiciones de crianza no son adecuadas, las infecciones ocasionadas por E. coli comprometen el bienestar de las aves.

Escherichia coli fue descubierta en 1886 por Theodor Escherich, quien encontró a este microorganismo en heces de niños, a partir de entonces se considera como un habitante normal de la biota intestinal de diversos animales y el hombre y juega un papel muy importante en la digestión y la regulación de la microbiota intestinal.
Esta bacteria pertenece a la familia
Enterobacteriaceae, es gram negativa, anaerobia facultativa; crece a temperaturas entre 15°C y 45°C, no produce esporas, puede ser móvil o inmóvil y normalmente es fermentadora de la lactosa, aunque existen cepas que no son capaces de utilizar este sustrato.
Tradicionalmente, su identificación en el laboratorio se basa en sus propiedades bioquímicas (Figura 1) ya que no se requieren equipos sofisticados, sin embargo, dada la diversidad de esta bacteria no es suficiente para conocer la virulencia de la cepa en cuestión, ni se logra diferenciar entre patotipos.
Por lo que se requiere recurrir a otros métodos para dilucidar si una cepa en particular tiene la capacidad patogénica para ser causante de un problema infeccioso en una parvada.
Este microorganismo ha sido clasificado en tres grandes grupos:
Cepas comensales
Cepas patógenas intestinales (InPEC) o diarreogénicas
Cepas patógenas extraintestinales (ExPEC), dependiendo de su potencial patógeno.
Como parte de este último grupo se encuentran las cepas uropatógenas (UPEC), las causantes de meningitis bacteriana (BMEC) y aquellas que ocasionan infecciones en aves conocidas como patógenas aviares (APEC).


La serotipificación ha sido empleada como una herramienta de gran utilidad para fines epidemiológicos, en el caso de esta bacteria se emplea el esquema de Kauffman-White, similar al de Salmonella que se basa en la identificación de antígenos somáticos “O”, capsulares “K” y flagelares “H”.

En el caso de E. coli se han identificado 197 antígenos somáticos, 80 capsulares y 60 flagelares.
Cuando solo se hace referencia al antígeno somático se le denomina serogrupo, y
Cuando se menciona el antígeno somático y el flagelar, entonces se le denomina serotipo.
En el caso del antígeno “O” es parte del lipopolisácarido (LPS) que forma parte de la membrana externa de las bacterias gram negativa, el cual está compuesto por el lípido A, el core interno, core externo y las cadenas laterales que son unidades repetidas de polisacáridos que contienen de 2 a 5 residuos de azúcares.
Como es evidente, la gran diversidad del antígeno “O” le ofrece ventajas a la bacteria para sobrevivir en nichos específicos, de hecho, se le considera un factor de virulencia muy importante, no solo para las cepas APEC, sino para las cepas ExPEC.
Ya que éste evita la unión de los anticuerpos del huésped a antígenos que se localizan en estructuras más internas en la bacteria, además, se sabe que evita la unión de los fagos a las proteínas de la membrana; incluso, se ha visto que este antígeno es capaz de inhibir la acción enzimática de la lisozima.
Por otro lado, el antígeno “O” es altamente inmunogénico y es el principal antígeno contra el que se monta la respuesta inmune, lo cual representa un gran desafío para la producción de vacunas, pues como se ha mencionado, se reconocen al menos 197 antígenos y entre la mayoría de ellos no se presenta una protección cruzada.
Hasta hace algunos años, se reconocía que los serotipos más comunes entre las cepas APEC eran O1, O2 y O78.
Sin embargo, a medida que se ha analizado más cepas involucradas en infecciones aviares se ha determinado que los serotipos varían dependiendo de la zona geográfica, momento del aislamiento, tipo de ave y localización de la infección.
Aunque la serotipificación pude ser muy útil para relacionar ciertos serotipos con algunos brotes de enfermedad, al igual que la identificación bioquímica, tampoco proporciona información sobre la virulencia de las cepas aisladas.
Es por eso por lo que se ha recurrido al uso de diversos métodos como los moleculares para lograr definir la virulencia de una cepa determinada.

En México, se han realizado diversos trabajos en los cuales se han serotipificado cepas aisladas entre 1997 y 2019 las cuales se obtuvieron a partir de reproductoras pesadas, reproductoras ligeras, incubadora, pollo de engorda, canales de pollo en plantas de procesamiento y puntos de venta, gallina de postura, aves de traspatio y codornices, en total se logró serotipificar 1235 cepas las cuales se muestran en la Figura 2.
Codornices
Aves de traspatio
Gallina de postura
Canales de pollo en punto de venta y...
Pollo de engorda
Incubadora
Reproductoras ligeras
Reproductoras pesadas
2. Origen de las 1235 cepas de E. coli aisladas en México que fueron serotipificadas de 1997 a 2019.
En total se logró identificar 131 diferentes serogrupos, de los cuales 30 solo se identificó una cepa, mientras que los más frecuentes fueron las cepas no tipificables, seguidas por las cepas O25, O8, cepas rugosas, O2 y O82, como se muestra en el Cuadro 1.
En éste se puede apreciar que la mayoría de los serogrupos encontrados no son los que tradicionalmente se han reportado como característicos de las cepas APEC.
Cuadro 1. Serogrupos más comunes de E. coli aisladas a partir de diferentes muestras de aves de 1997 a 2019.
Cuadro 2. Serogrupos comunes de E. coli aisladas entre los grupos con mayores números de cepas analizadas.
Adicionalmente, se compararon los serogrupos que se encontraron con mayor frecuencia en las muestras de las cuales se contaban con mayor número, lo cual se observa en el Cuadro 2.
En éste puede apreciar que O19 y O84 fueron comunes en pollos y canales de pollo tanto en punto de venta como en plantas de procesamiento;

Mientras que en el caso de las cepas O82 y O153 se encontraron tanto en canales como en gallinas de postura; Finalmente, se encontraron serogrupos comunes en pollos, canales y gallinas, como O2, O8, O25 y O103, por lo que podrían considerarse como candidatos para la elaboración de algún inmunógeno para la prevención de la colibacilosis aviar.
Las cepas APEC han sido implicadas en una gran variedad de enfermedades extraintestinales en diferentes especies aviares, desde infecciones localizadas, tales como:
Onfalitis, infección del saco vitelino, celulitis, síndrome de cabeza hinchada, diarrea, infecciones venéreas, salpingitis, salpingoperitonitis y peritonitis, orquitis y epididimitis;
Cabeza: Síndrome de cabeza hinchada
a
Corazón:
Miocarditis y pericarditis, a menudo con depósitos brinosos
Hígado:
Perihepatitis, a menudo caseosa. Lesiones hepáticas manchadas
Patas: Pododermatitis ulcerativa (Bumblefoot)
Infecciones sistémicas como colisepticemia de origen respiratorio, entérico, neonatal o secuelas de estas infecciones como meningitis, panoftalmitis, osteomielitis, espondilitis, artritis, sinovitis y salpingitis, entre otras.
Esta misma versatilidad ha puesto en tela de juicio si en realidad el grupo APEC puede ser considerado como un solo patotipo o si existen subpatotipos que sean los responsables de los diferentes síndromes y que, por tanto, posean genes de virulencia específicos que ocasionen las manifestaciones clínicas ocasionadas por E. coli en las aves.
Pulmones y sacos aéreos: In amación (aerosaculitis)
Exudado en pulmones y sacos aéreos - Di cultad respiratoria

Propagación desde los alvéolos hasta el tejido subyacente del tracto reproductivo
Riñón: Nefritis y lesiones
Aparato reproductor: Síndrome de salpingoperitonitis (SPS)
Infección cloacal ascendente del tracto reproductivo
Propagación extraintestinal desde el tracto gastrointestinal a otros órganos


Una de las principales vías de entrada de APEC es a través del tracto respiratorio por la inhalación de polvo contaminado, para lo cual la adhesión a la tráquea es un paso inicial crítico para provocar una septicemia posterior; una estructura importante en este proceso es la fimbria tipo 1 que se adhiere a los residuos de D-manosa de las células epiteliales de la tráquea y faringe mediante la adhesina FimH.
Se sabe que los aislamientos bacterianos que colonizan la tráquea, pulmones y los sacos aéreos comúnmente expresan la fimbria tipo 1, mientras que en el caso de aquéllas que son capaces de colonizar tejidos internos o provocar septicemia no lo hacen.
En contraste las cepas que ocasionan infecciones en sacos aéreos, pulmones u órganos internos expresan fimbria tipo P, cuya adhesina PapG que se une al glicolípido galabiosa;
Esta adhesina tiene tres variantes alélicas, de las cuales, se reporta que la mayoría de las cepas APEC poseen PapGII.
Sin embargo, en un trabajo en el cual se detectaron diversos genes en 30 cepas de E. coli aisladas a partir de gallinas de postura con peritonitis en la región de los Altos de Jalisco, solamente una de ellas fue positiva a dicho gen, mientras que el 100% fueron positivas a FimH.
Otros factores críticos para la virulencia de E. coli son los sistemas de adquisición de hierro a través de los sideróforos; se ha reportado que el 40% de las cepas de APEC poseen el sistema aerobactina, mientras que solamente se encontró en el 30% de las cepas aisladas de aves sanas.
Estos factores de virulencia son regulados por sistemas de comunicación bacteriana (quorum sensing) a través de autoinductores, de ellos, el autoinductor 2 (AI-2) se encuentra ampliamente distribuido entre diversas bacterias, además de jugar un papel crucial en la sobrevivencia y la formación de biofilms.
Existen dos tipos de receptores del AI-2, LuxP y LsrB, ambos son capaces de unirse al AI-2 a pesar de tener una estructura diferente; recientemente Zu et al. (2009) demostraron que la deleción del operon lrs, compuesto de 8 genes, entre ellos lrsB, disminuía 294 veces la virulencia en cepas APEC ya que la cantidad de bacterias presentes en sangre, hígado, bazo, riñón, fue significativamente menor que en la cepa silvestre.

A pesar de todos los factores que se han descrito en las cepas APEC, Johnson et al. en 2008, después de analizar un numero importante de genes de virulencia llegaron a la conclusión de que la mayoría de las cepas virulentas poseían al menos tres de cinco genes que se podían identificar a través de una prueba de PCR multiplex a la que se le denominó pentaplex y que se muestra en el Cuadro 3.
GEN FUNCIÓN
iroN
ompT
hlyF
iss
Gen del receptor de la salmoquelina
Gen de una proteasa episomal de membrana externa
Gen de la hemolisina aviar putativa
Gen de incremento a la supervivencia al suero episosomal
iutA Gen del receptor del sideróforo aerobactina
Cuadro 3. Genes de virulencia que se consideran en el pentaplex para determinar la virulencia de las cepas APEC de E coli.
Sin embargo, cabe mencionar que en nuestro laboratorio se han encontrado cepas que han mostrado su virulencia en aves y en pruebas de letalidad embrionario que no los poseen, lo que refuerza la idea de la existencia de subpatotipos.
Un ejemplo de ello es lo encontrado en el estudio realizado por Maturana et al. quienes observaron que cepas aisladas de diferentes síndromes poseían algunas características comunes entre ellas, pero que a su vez difieren de los que se encontraron en otros síndromes, lo que sugiere que, efectivamente, APEC no es un patotipo homogéneo.
Estos hallazgos han llevado a que diversos grupos alrededor del mundo se encuentren estudiando a las cepas APEC, lo que sin duda redundará en el mejor entendimiento de los mecanismos de virulencia y la patogenia de las cepas APEC, y, en consecuencia, en el diseño de mejores estrategias para controlar el impacto en la salud de las parvadas avícolas y económico en los productores.
E. Coli patogénica aviar (APEC): serotipos y virulencia
DESCÁRGALO EN PDF










Lesly Romero Beltrán-Gerente División Comercial Aves Contenido de Sanfer Salud Animal
El virus de la Influenza Aviar fue descrito por primera vez en 1878 en Italia, por Edoardo Bellarmino Perroncito, quien la describió como una enfermedad contagiosa en las aves, con alta mortalidad.
Se le denominó plaga aviar y era comúnmente confundida con el cólera aviar.




En 1880 Divolta y Delprato describieron las diferencias con el cólera aviar y llamaron a esta enfermedad Typhus exudiatious gallinarum.
A principios de 1900 se publicaron tres artículos en donde se describía que el agente causal de la plaga aviar era un agente filtrable, un virus.
El primer registro de Influenza Aviar en Norteamerica es en 1924 en la Ciudad de Nueva York, donde se presentaron pérdidas importantes en los mercados de aves vivas.
A partir de ese momento la enfermedad empezó a diseminarse por otros Estados, como Connecticut, Missouri e Indiana, en todos los casos asociados a la importación de aves de áreas donde previamente se había presentado la enfermedad.
En 1925 se tomaron medidas de cuarentena, despoblación y desinfección, con lo que se logró erradicar la enfermedad antes de que se dispersara por todo Estados Unidos.
El siguiente brote del que se tiene reporte es en 1983 y se trata de un virus H5N2, este subtipo continúa en circulación y los virus de Influenza Aviar actualmente continúan siendo un problema importante en la avicultura mundial.
Los virus influenza pertenecen a la familia Orthomyxoviridae Existen cuatro tipos de virus Influenza A, B, C y D.
La clasificación se basa en la secuencia de aminoácidos de la nucleoproteína (NP) y de la proteína de matriz 1 (M1).
Los virus de tipo B y C son exclusivamente de humanos, mientras que D se ha aislado en animales.
Los virus tipo A y B tienen genomas segmentados de 8 segmentos, mientras que los C y D presentan 7 segmentos.
Aunque los virus de Influenza A y los virus de Influenza B son muy similares en estructura, los virus de Influenza B tienen una tasa de mutación más lenta.
Por lo que la distribución de sus linajes permanece muy estable, contrario a lo que sucede con los virus de tipo A.
Los virus tipo A puede infectar a humanos y a otros mamíferos, los principales reservorios de este tipo de virus son las aves migratorias, dentro de los virus de Influenza A se encuentran los virus de Influenza Aviar.



La clasificación de los subtipos de virus Influenza A, depende de la combinación de Hemaglutinina (HA) y Neuraminidasa (NA) que presenten, la diferencia de nucleótidos entre subtipos debe ser al menos un 30%. Hasta el momento se han reportado 18 subtipos de HA y 11 subtipos de NA.
El virus Influenza A es pleomórfico, su diámetro varía de 50 a 120 nm, cuenta con una bicapa lipídica tomada de la membrana celular.
En el interior del virión se encuentra la proteína M1, y la nucleocápside helicoidal;

En el exterior, insertadas en la membrana lipídica, se encuentran las glicoproteínas HA y NA, que son los principales antígenos de superficie, y las proteínas virales que presentan la mayor diversidad aminoacídica en sus secuencias.
Los virus Influenza A tienen un genoma de RNA de cadena sencilla, en sentido negativo, de 8 segmentos. Algunos segmentos del genoma de Influenza codifican para más de una proteína dependiendo del marco de lectura.
El genoma se encuentra empaquetado en estructuras conocidas como ribonucleoproteínas (RNP) conformadas por el RNA viral, la NP y el complejo de las polimerasas: Polimerasa básica 1 (PB1), polimerasa básica 2 (PB2) y polimerasa ácida (PA).

La HA es una glicoproteína integral de membrana, que se encuentra como principal antígeno de superficie, constituye alrededor del 80% de las proteínas expresadas en la superficie viral.
Se empaqueta en el retículo endoplásmico en forma de homotrímeros cilíndricos:
Cada homotrímero consiste en un tallo fibroso, que en un extremo se inserta en la membrana viral;
Mientras que en el otro extremo se encuentra el dominio globular con tres sitios de unión para el ácido siálico, un sitio por cada monómero de HA.
Los monómeros de HA son sintetizados como HA0, este precursor es inactivo, por lo que no puede infectar hasta ser cortado por enzimas proteolíticas.
En los virus aviares el sitio de corte determina la patogenicidad de la cepa viral, la cual puede ser de baja o alta patogenicidad.
Los virus de baja patogenicidad al igual que los virus humanos tienen un sitio de corte monobásico.
Los virus de baja patogenicidad son digeridos por enzimas proteolíticas tipo tripsina (serina proteasa y triptasa clara), que se encuentran en el tracto respiratorio y en el tracto gastrointestinal, lo que conlleva a que la replicación viral se vea limitada.
Mientras que los virus de alta patogenicidad contienen un sitio de corte polibásico, con una mayor cantidad de argininas y lisinas, lo que permite que sean digeridos por enzimas intracelulares como las proteasas ubicuas, resultando en una diseminación viral sistémica.
La patogenicidad debe relacionarse con el comportamiento clínico, ya que los virus de alta patogenicidad deben ocasionar alta mortalidad al inocularse por vía intravenosa en pollos.
Los subtipos H5 y H7 han sido los únicos identificados como virus de alta patogenicidad, aunque hay variantes de estos mismos subtipos con un comportamiento y un sitio de corte de baja patogenicidad.
Los virus de alta patogenicidad ocasionan pérdidas importantes en las producciones avícolas, ya que pueden llegar a ocasionar la muerte del 100% de las aves afectadas.
Se estima que más de 500 millones de pollos han muerto a causa de estos virus, lo que ha tenido fuertes repercusiones económicas.

La capacidad que tienen los virus de Influenza de cambiar su genoma para evadir la respuesta inmune del huésped se conoce como variación antigénica.
El proceso puede ser puntual y gradual, en ese caso la capacidad mutagénica conduce a cambios en las principales proteínas de superficie del virus, esto se conoce como deriva antigénica o antigenic drift.
Sin embargo, este no es el único mecanismo de cambio presente en los virus de Influenza.
Ya que estos virus tienen la capacidad de recombinarse cuando dos o más virus distintos infectan una misma célula, a esta capacidad de recombinación que conlleva al surgimiento de nuevos subtipos, que pueden modificar la capacidad de infectar nuevos huéspedes y saltar la barrera interespecie.
Lo cual se relaciona con el surgimiento de virus pandémicos, ya que pueden generarse virus contra los cuales el huésped no tenía ningún tipo de protección, a esto se le llama cambio antigénico o antigenic shift.
Desde la primera identificación de un virus de Influenza Aviar a la fecha, hemos detectado una alta capacidad de cambio y adaptación, tanto en presentaciones de subtipos, recombinaciones genéticas, mutaciones para evasión de la inmunidad.
O para cambiar la presentación clínica de la enfermedad, siendo la HA la proteína que más cambios presenta, es importante seguir de cerca los cambios por venir ya que al monitorear podremos estar listos para prevenir complicaciones asociadas a la alta tasa de mutación de los virus de Influenza Aviar.

Influenza Aviar, el cambio es lo único constante
DESCÁRGALO EN PDF




Eric L. Jensen1 y Dra. Carolyn L. Miller2 1DVM, MAM, diplomado de la ACPV, 2DVM, MAM, diplomada de la ACPV (2001).
Revisado por Jose J. Bruzual DVM, MAM, MSc, diplomado del APCV, PAS Contenido de Aviagen

En la continuación del artículo exploraremos señales clínicas y lesiones macroscópicas, factores clave para disminuir las infecciones y su tratamiento.
SEÑALES CLÍNICAS Y LESIONES MACROSCÓPICAS
La enfermedad estafilocócica relacionada con el huevo y la planta de incubación se evidencia en pollitos deprimidos, una mortalidad temprana elevada (primeras 2 semanas), ombligos húmedos o sin sanar, y onfalitis.
Otro factor que predispone a las enfermedades son las abrasiones en la piel (tarsos rojos) durante el nacimiento. También se puede producir una infección en el hueso (osteomielitis),que suele causar la necrosis de la cabeza femoral.

Los pollos con artritis y tenosinovitis evidencian cojera. La articulación del tarso suele estar comprometida, inflamada y caliente al tacto. La articulación de la rodilla es la segunda articulación más afectada. Al abrir la articulación y el tejido circundante, se observa un exudado caseoso de color amarillo o blanco. La inflamación también puede ser evidente en la superficie articular y los tendones cercanos.
Con trabajo experimental, se ha demostrado que la infección temprana con Staphylococcus o reovirus puede causar inflamación en la articulación del tarso y los tendones cercanos (Hill, et al., 1989).
La infección crónica de los tendones con cualquiera de esos organismos causa fibrosis progresiva y calcificación. A medida que las aves aumentan de peso o se los ubica en los galpones con slats (rejillas), esos tendones pueden romperse y causar una pérdida permanente del uso de la pierna afectada.
Se puede formar un nudo grande (fibrosis) en el lugar de la ruptura. Se debe pensar en un diagnóstico diferencial para la artritis del reovirus usando una combinación de lo siguiente:
Serología.
Histopatología.
Aislamiento del virus.
Identificación del virus por medio del análisis molecular.
Sin embargo, el diagnóstico se dificulta si han pasado más de 5 semanas desde la infección, porque las lesiones microscópicas importantes se vuelven similares con el paso del tiempo.
A partir de la mayoría de la evidencia de problemas de campo, no se logra probar de forma satisfactoria que los reovirus son la causa, y la mayoría de los tejidos han mejorado o se curaron sin cambios en la situación del reovirus de la parvada.


Inicialmente, el área que rodea el tendón roto — generalmente se observa en el tendón gastrocnemio, por encima del tarso— cambia de color, se vuelve de color rojizo - púrpura por la hemorragia, y luego, pasa a verde (Figura 3).



Figura 3. Tendones rotos: (A) color verdoso, (B) tendón roto (hemorragia), (C) tendón roto expuesto.
Las infecciones estafilocócicas del cojinete plantar y las falanges (pododermatitis) son comunes en los pollos adultos (Figura 4). La inflamación grave del cojinete plantar y las falanges causa la cojera subsiguiente.




Figura 4. Absceso plantar o pododermatitis.

La osteomielitis puede causar cojera o parálisis según si se ve afectado un hueso largo o la columna vertebral (Figura 5). Las zonas óseas que suelen verse afectadas son la cabeza proximal del tibiotarso, el fémur proximal (caderas) y las vértebras torácicas libres (T4).
Figura 5. (A) Osteomielitis en el extremo proximal de la tibia, (B) necrosis en la cabeza femoral leve,(C) necrosis en la cabeza femoral aguda, (D) y (E) Osteoartritis Vertebral (VOA), vértebras torácicas libres.


Las aves con infecciones en los huesos de las piernas se niegan a caminar. Cuando el fémur se ve afectado, la sección proximal del fémur se rompe de la diáfisis cuando se desarticula la cabeza femoral de la articulación de la cadera (necrosis en la cabeza femoral).
Las lesiones macroscópicas pueden incluir exudado amarillo - marrón o necrosis en la cabeza del fémur (metáfisis). Las infecciones en los espacios articulares entre las vértebras pueden causar parálisis en las piernas. Suele necesitarse un examen histológico del tejido fijado con formalina para un diagnóstico preciso.




FACTORES CLAVE PARA DISMINUIR
LAS INFECCIONES ESTAFILOCÓCICAS EN LA POBLACIÓN DE REPRODUCTORAS:

1. Manejo de los huevos para incubación: higiene del huevo y la granja
Use la temperatura apropiada en la sala de huevos de la granja para evitar la condensación.
Recolecte los huevos con frecuencia y mantenga el nido limpio.
Manipule los huevos siguiendo las prácticas recomendadas de la granja.
Siga pautas de sanitización estrictas.
No envíe huevos del piso a la planta de incubación.
2. Manejo y sanitización de la planta de incubación: higiene del huevo y la planta de incubación
Incube huevos limpios.
Evite la condensación de los huevos.
Use correctamente las lavadoras de bandejas y de las cajas de pollitos.
Use bandejas para huevos, bandejas de incubación y cajas de pollitos limpias.
3. Manejo de la granja: factores que afectan la comodidad y el bienestar de las aves
Brinde el espacio recomendado para los comederos.
Brinde las densidades poblacionales recomendadas.
Distribuya el alimento a todas las aves en tres minutos.
Siga las pautas y las metas de peso recomendadas, y la uniformidad de las aves.
Aumente la cantidad de alimento con frecuencia durante el período de levante.
Asegúrese de que haya dos puntos de contacto en el ave: ambas piernas, las alas o los costados (se recomienda la manipulación mínima).
Maneje las aves para lograr la sincronización sexual entre los machos y las hembras.
Garantice el correcto manejo del alimento y la iluminación durante el inicio de la madurez sexual o la producción de huevos.
Aplique las relaciones de apareamiento recomendadas.




Motive el uso de los sistemas de sanitización de agua.
Use un sistema de agua cerrado.
Use una buena calidad de cama.
Maneje la calidad de la cama mediante la ventilación y la remoción de la cama apelmazada.
Retire objetos afilados.
Motive el ejercicio con la iluminación adecuada, perchas y slats (rejillas) de entrenamiento. Permita el acceso a las perchas a partir de los 28 días de edad.
Instale los slats (rejillas) a un máximo de 25 a 30 cm (10 a 12 in) y manténgalas en buen estado.
Use rampas para ayudar a las gallinas a subir a los slats (rejillas).
Incorpore una baranda adecuada de descenso / perchas en el diseño de las cajas nido.
Garantice la bioseguridad apropiada en la planta de incubación y en la granja.
Garantice niveles altos de inmunidad materna usando los programas de vacunación apropiados.
Monitoree y controle la coccidiosis y otros problemas intestinales.
Cuando use vacunas respiratorias más virulentas, primero exponga las aves a cepas intermedias o leves. Evite las reacciones “rodantes”.
Prevenga la contaminación de la vacuna y la aguja cambiando con frecuencia la aguja y el aplicador de la membrana del ala.
Use prebióticos y probióticos para ayudar a establecer la flora intestinal apropiada en forma temprana.

El tratamiento de la estafilococosis varía en eficacia, pero puede ser conveniente y ventajoso para el bienestar del ave.
La mayoría de los S. aureus aislados de los pollos son sensibles a la penicilina, pero siempre se deben hacer pruebas de sensibilidad, porque la resistencia antibiótica es común.

La resistencia a la penicilina puede generarse rápidamente en las aves en tratamiento, por lo que puede ser beneficioso cambiar a otro antibiótico después de 5 a 7 días de tratamiento con penicilina.
Otros antibióticos solubles en el agua que pueden ser efectivos incluyen la eritromicina, la lincomicina y las tetraciclinas, aunque no están disponibles en todos los países. Consulte con su veterinario avícola sobre el tratamiento con antibióticos, ya que algunos antibióticos solo pueden usarse con receta de un veterinario certificado.
Los antibióticos son más efectivos si se administran en la etapa temprana de la enfermedad.
Las infecciones establecidas —especialmente con artritis y osteomielitis— no responden a los medicamentos debido al nivel de daño ya causado en la articulación y el hueso, o a la dificultad para lograr la concentración adecuada de antibióticos en el lugar donde se concentra el daño. Lo mejor es remover esas aves de la parvada.
Las soluciones a largo plazo más efectivas a la estafilococosis son centrar las prácticas de manejo en la prevención minimizando todos los factores que podrían contribuir a la infección estafilocócica.
Esto supone identificar y eliminar las posibles fuentes de estafilococos y reducir los factores que podrían aumentar la susceptibilidad de las aves a la infección.
Considere reducir la carga bacteriana general practicando la limpieza y desinfección óptimas, especialmente después de las parvadas que tuvieron una infección por Staphylococcus.
Además, promover las prácticas recomendadas de cría animal mejora el entorno de las aves y ayuda a reducir el riesgo de infecciones estafilocócicas.
REFERENCIAS BAJO CONSULTA DEL AUTOR.
Infección por estafilococo en la población de reproductoras - Parte II DESCÁRGALO EN PDF



Invertimos en investigación para lograr un progreso equilibrado y sostenible de la salud y productividad de las aves.



M.V. Bruno Vecchi1 y M.V. Cecilia Rodríguez2
1 Gerente Técnico Avícola
2 Redactora Técnica Contenido de Vetanco
En la cadena de producción de alimentos intervienen varios actores, desde la generación de las materias primas, pasando por la transformación de dichos compuestos hasta el producto final.
En la producción animal, el alimento es uno de los factores clave. En una primera etapa se encuentra la producción de cereales, los cuales llegan a las fabricas de alimento para generar el balanceado que consumen los animales que serán engordados para luego obtener el producto final que consumirán las familias.




Este proceso mantiene un equilibrio delicado en donde cada actor busca la generación y utilización de insumos de la mayor calidad posible.
Sin embargo, muchas veces hay desvíos que son difíciles de identificar y que si no se tienen en cuenta pueden representar no solo una merma productiva sino un riesgo para la salud.
Las micotoxinas son metabolitos secundarios tóxicos producidos por diversos hongos filamentosos, principalmente de los géneros:
Aspergillus, Penicillium, Fusarium.
Estas sustancias representan una de las principales amenazas para la producción animal, ya que pueden contaminar los granos y subproductos utilizados en la formulación de alimentos, generando efectos adversos en la salud, el rendimiento productivo y la seguridad alimentaria.
Pero el riesgo comienza mucho antes, en el grano, ya que la contaminación fúngica de los granos tiene un impacto directo en la calidad de estos.
Schmidt et al, observaron que los granos contaminados con hongos pueden perder hasta un 20% de los carbohidratos disponibles, lo que representa una disminución significativa de la energía que aportan, algo fundamental y que muchas veces no se tiene en cuenta, a la hora de formular una ración.

Cuando las plantas contaminadas con hongos atraviesan situaciones de estrés, como temperaturas extremas, inundaciones o heladas, los hongos producen las toxinas como mecanismo de defensa.
Si bien cada hongo tiene una predilección por algún sustrato en especial, todos pueden contaminar cualquier tipo de cereal.
A su vez, los hongos rara vez producen solo una micotoxina, sino que, según las condiciones y especie de la que se trate, pueden producir varias en simultáneo. Es así como por ejemplo los hongos del genero Fusarium son capaces de producir:
Fumonisinas,
Tricotecenos,
Zearalenona.
Las micotoxinas son sumamente tóxicas, concentraciones extremadamente bajas ya pueden causar alteraciones metabólicas.
Cuando hablamos de “bajas” nos referimos a ppb que es lo mismo que tratar de identificar a 8 personas puntuales en la población mundial.
Además, debido a su estabilidad química y resistencia a los procesos industriales de procesamiento y almacenamiento, las micotoxinas pueden persistir en los alimentos y representar un riesgo significativo tanto para los animales como para los humanos a través de la cadena alimentaria.

Los efectos de las micotoxinas en los animales y humanos pueden ser muy diversos y dependen no solo del tipo de micotoxina sino de la concentración y tiempo de exposición.
Concentraciones bajas pueden no tener un efecto serio, pero si la exposición es prolongada en el tiempo puede complicarse el cuadro.


Oxidación

Inflamación Inmunosupresión Alteraciones macroscópicas
Gráfica 1. Concentración de micotoxinas. Creado en https://BioRender.com

Un trabajo realizado por Grenier y Applegate muestra cómo en primera instancia, en bajas concentraciones, las micotoxinas generan cuadros de desbalance metabólico e inflamación.
Estos cuadros pueden no tener mayor complicación que la merma productiva, sin embargo, a medida que la dosis aumenta, pasamos a situaciones más complejas como la inmunosupresión, o incluso manifestaciones clínicas.
Como si esto fuera poco, las micotoxinas poseen efectos sinérgicos y aditivos, es decir, cuando dos o más micotoxinas están presentes sus efectos se potencian.
Así, por ejemplo, Aflatoxina B1 es capaz de incrementar la producción de ácidos biliares y disminuir la descarga de estos a nivel del colédoco, generando una colestasis (Yu et al).
Si a ese cuadro le sumamos tricotecenos (DON), el cual es capaz de inhibir el mecanismo de reabsorción intestinal de los ácidos biliares (Wang et al), tenemos una alteración grave del mecanismo de regulación de los ácidos biliares y los problemas asociados al mismo.
Debido a esto, realizar un correcto monitoreo de las prevalencias de micotoxinas, año tras año, resulta fundamental para poder establecer programas de control integrales que sean capaces de hacer frente a los distintos desafíos que esta problemática arroja.
Vetanco S.A. trabaja desde hace varios años en el monitoreo y control de micotoxinas a nivel mundial.
En Latinoamérica lleva a cabo un survey de micotoxinas desde el 2016, registrando los cambios de prevalencias que ocurren año tras año. Con un volumen de muestras cercanas a las 13.000, estos surveys permiten aproximarse a la situación real de desafío, algo que sería muy difícil de lograr en pequeña escala.

El 2024 fue un año que continuó una tendencia preocupante, marcado por las elevadas temperaturas en Brasil y la Argentina y con lluvias concentradas en pequeños periodos de tiempo, el cambio climático permitió la propagación y producción de lo que hoy en día ya es una constante: el hongo Fusarium con su producción de Fumonisinas.
Sin embargo, el dato más preocupante es el porcentaje de co-contaminaciones (muestras positivas a dos o más toxinas), el cual alcanzó la alarmante cifra de 68% (el promedio de los últimos años suele estar en 40%).
Esto es un problema no solo por el efecto que puede tener en la salud de los animales, sino también porque son necesarias herramientas de control mucho más sofisticadas para poder eliminar una contaminación múltiple.


Con respecto al análisis individual por toxina, la principal micotoxina es la FUMONISINA con una prevalencia del 79%, seguida por ZEARALENONA con el 74% y DON con el 48%. Esto marca claramente la dominancia del hongo Fusarium ya que son las tres toxinas que él produce.
Cuando observamos los niveles de Fumonisina en Latinoamérica, vemos que los países ubicados más al sur son los más complicados, mientras que los ubicados más al norte, o sobre la costa atlántica, tienen una contaminación menor.
Esta situación, que afecta la región hace más de 5 años, hace que sea necesaria la correcta elección de estrategias de mitigación.
Gráfica 3. Concentraciones promedio en ppb por país. Colombia 1310
México 1030 980
Ecuador 2080
Bolivia 3840 Perú 2700
Urugay 2250 Argentina 2860

Las micotoxinas se absorben casi exclusivamente a nivel intestinal, por lo que se pueden utilizar productos para evitar que las mismas lleguen al intestino o que sean absorbidas por este.

Las Aflatoxinas y alcaloides del ergot son las toxinas que mejor se pueden controlar con este mecanismo. Las Fumonisinas también pueden ser potencialmente secuestrables, sin embargo, debido a su gran tamaño, muchas veces es necesario utilizar grandes cantidades de secuestrante para obtener resultados adecuados.
Por otro lado, la acción de los secuestrantes no es específica, es decir, actuarán sobre cualquier molécula que tenga polaridad.
En los últimos años se han desarrollado estrategias de control mucho más tecnológicas de la mano de las enzimas.
La selección de enzimas específicas que sean capaces de actuar dirigida y exclusivamente sobre la toxina para la cual se la seleccionó es, hoy por hoy, la mejor estrategia de control contra las micotoxinas.
Micotoxina

Sitio activo

Cada enzima es especifica para una micotoxina o familia de micotoxinas
Esta estrategia no solo permite eliminar las toxinas independientemente de sus propiedades fisicoquímicas, sino que también permite armar productos que eliminen varias toxinas simultáneas, algo fundamental en esta situación de desafío múltiple.
Además, las enzimas suelen ser muy eficientes, por lo que con bajas tasas de inclusión suele bastar para hacer control a los desafíos habituales.
Con presencia a nivel mundial, Detoxa Plus es una de las mejores opciones para el control de desafíos múltiples de micotoxinas en la producción animal.
Con su formulación multienzimática, posee las enzimas necesarias para eliminar las principales micotoxinas presentes en los alimentos de los animales, asegurándose la inocuidad de los alimentos y el máximo desempeño productivo.


Productos NO TOXICOS
Son productos seguros y no tienen actividad sobre otros componentes como antibióticos o vitaminas Enzima
Complejo ENZIMAMICOTOXINA
Gráfica 4. Uso de enzimas para el manejo de micotoxinas.
Desafíos actuales de micotoxinas en Latinoamérica DESCÁRGALO EN PDF
Biografía bajo consulta al autor

Ing. Jorge Robles
Gerente General de Producción Redondos S.A. Perú


En esta segunda parte del artículo se resalta que es vital cumplir con la demanda de huevos incubables del cliente en Incubación, asegurando cantidad, calidad y costos optimizados, que afectan el precio del pollito.
Indicadores de productividad son herramientas que se utilizan para medir la eficiencia dentro de la empresa; es decir, el rendimiento de los procesos que se están llevando a cabo en la operación productiva.
Los Indicadores productivos tienen una importancia crucial en toda explotación pecuaria ya que sin estos es difícil saber si el manejo es adecuado o no, y, en consecuencia, no se puede tomar las decisiones correctas, para corregir el o los problemas que puedan afectar a la producción.
Dentro de estos tenemos: la Mortalidad, Índice de Conversión Alimenticia, Edad y Peso, tal y como se muestra en el Gráfico 1.

Gráfico 1. Indicadores productivos en pollos de engorde
Para efecto de poder integrar los 4 indicadores mencionados, en un único factor que permita evaluar el rendimiento productivo (y comparar la performance operativa entre diferentes lotes, granjas, zonas productivas, etc.), podemos utilizar el Factor de Eficiencia Europeo, como un número absoluto de comparación (sin incluir ni comparar costos productivos),
donde un mayor número indicaría un mejor rendimiento operativo, evidentemente en similares condiciones de operación.
La manera clásica de calcular el FEE es la que se muestra a continuación:
% viabilidad / conversión alimenticia = x FEE
Peso promedio / Edad 100
¿Cuál es la importancia de los Costos de Producción?
Los costos son un concepto fundamental en toda organización porque permiten determinar el resultado (Ganancia o Pérdida: Ingresos – (Costos + Gastos)) de las operaciones productivas (además de ser una herramienta fundamental para la toma de decisiones),
siempre que se estimen de forma real y se complementan adecuadamente con el concepto de gastos de operación.
¿Por qué es importante clasificar los costos?
La correcta asignación de costos (y entre más precisa sea la asignación, será mejor la estimación), dará como resultado un mejor costeo de los productos.
Esto permite a la organización, a partir del establecimiento de un precio de venta, conocer (a nivel de mercado), qué tan eficientes se están llevando a cabo los procesos de la empresa.
¿Cuál es la importancia de una adecuada
Tener un Sistema de Costo bien estructurado e identificado, permitirá distribuir correctamente los costos, y evaluar los costos variables (en relación con el nivel de producción), y los costos fijos (en relación con el tamaño de la empresa),
y proyectar los resultados económicos parciales y totales de la empresa, ayudando a controlar las finanzas empresariales y por consecuencia, la rentabilidad de la empresa.
El sistema de costos empleado para la valorización de los inventarios es el de Procesos Continuos bajo la metodología del Costo por Absorción tomando en cuenta los costos históricos que se encuentran en los registros contables de nuestra empresa.

Para este artículo, nos enfocaremos en el Costo de Producción por Kilo de Pollo Vivo, considerando el producto final para un Mercado de Aves Vivas o como un Costo de Transferencia para un proceso ulterior y un valor agregado específico.
Michael Porter menciona que existen 2 posibles Ventajas Competitivas en el Mercado:
Como la capacidad de ofrecer un producto a un precio inferior y obviamente partiendo de un menor costo.
Como la capacidad de ofrecer un producto distinto y más atractivo para los consumidores, frente a los productos ofrecidos por los competidores.
Bajo esta premisa, nos enfocaremos en la Optimización del Costo de Producción por Kilo de Pollo Vivo, como eje principal de las 2 ventajas competitivas.
A continuación, evaluaremos los puntos relevantes en el proceso básico de producción del pollo de engorde:
Planta de Alimentos Balanceados.
Área de Reproductoras.
Área de Incubación.
Área de Engorde.
Área de Sanidad. Inmersa en todas las áreas productivas.
Pollo BB Abuelo importado (Genética) BB Reproductor
Granja de Reproductores
Huevos fértiles de pollos de engorde
Granja de abuelas

Venta de Pollo vivo
Planta de procesamiento de aves
Centro De Acopio Huevos fértiles
Planta de incubación de BB Reproductores
Planta de incubación de BB Engorde
BB de engorde
Granja de engorde de pollos
Planta de Alimentos Balanceados
Gráfico 2. Proceso productivo de pollos de carne.
En la coyuntura actual (con los altos costos de la MP y demás componentes alimenticios), el alimento se convierte en el factor de costo relevante y tenemos que trabajar para optimizar su respuesta productiva.
La tecnología orientada a nuevos y eficientes modelos de formulación (nutrición de precisión), tecnología de planta, uso de NIR, aditivos de alimentos específicos (enzimas, promotores, moduladores, etc.), juegan un rol importante que debemos adaptar a nuestras propias condiciones.
Esto es muy importante y hay que tener muy claro que lo que funciona bien y de manera eficiente en una operación productiva, no necesariamente funciona bien en la propia y viceversa.
Hay muchos factores que interrelacionan entre sí y pueden generar respuestas diferentes.
Pollo Procesado
Comercialización
Estamos considerando aspectos de Gestión Integral de la Producción; por lo tanto, asumimos que los temas de Manejo Nutricional, Crianza, Sanitario, Operativo y aspectos netamente técnicos se mantienen como constantes y realizados por los equipos especializados de cada empresa y bajo sus supuestos y lineamientos de operación.
Objetivo: Optimizar el Costo de Alimento x Kilo de Peso Vivo
Costo de alimento / Kilo Peso Vivo = Conversión alimenticia x Costo de Alimento
El enfoque estará orientado a obtener el menor costo como producto de la relación de estos 2 factores, pero lógicamente, teniendo como constantes la Ganancia diaria, la Edad de SACA y el Peso promedio de saca.
Importante: Definir el producto final según Programa del Área Comercial.

Elementos Materia
Gráfico 3. Elementos de costos en la planta de alimento balanceado.
Elementos
Maíz importado
Gráfico 4. Costo de materias primas en procesar alimento balanceado.
En la Planta de Alimentos, tendremos que evaluar puntos críticos de Operación, Monitoreo y Control:
Balance de Materia: Análisis de Inventarios Físicos (< 1%). Valorización.
Balance de Energía Eléctrica y Combustibles: Kwh / Ton + Litros /Ton.
Productividad por Producto (Ton / hora / Alimento)
Mano de Obra Directa (MOD) + Manos de Obra Indirecta (MOI) / TON.
Programa Optimo de Producción: < Tiempos Muertos Máquinas (< 10%)
Capacitación y Compromiso del Equipo Productivo.
El Costo de Procesar el Alimento Balanceado debería ser inferior al 5% del Costo Total/Ton producida, y dependerá del valor de la Materia Prima.
Sin embargo, su efecto es muy crítico y se correlaciona directamente con los resultados en campo y con su efecto en el resultado económico final de la empresa.
Por esta razón, si debemos priorizar inversiones, la Planta de Alimentos es nuestra primera opción.
Mientras mejor definida esté la estructura de costos del proceso de producción del alimento balanceado, mejor podremos actuar en las acciones correctivas y en la mejora del proceso.
La crianza de aves reproductoras para la obtención de huevos incubables, se desarrolla en dos etapas básicas:
Levante-Recría (0-24 SEM)
Producción (25-64 SEM)
Dependiendo de la naturaleza del negocio, se puede acortar o alargar el período de producción. Tiene que ser evaluado en términos económicos y de estrategia.
La etapa de levante-recría o desarrollo es una fase de capitalización de la futura reproductora desde que se recibe como pollita BB.
Todos los costos y gastos incurridos en esta fase de recría serán acumulados y asumidos por las gallinas que iniciarán la fase de producción.
De acuerdo con las normativas contables, cada período asume una parte representativa del valor del ave como costo del periodo. A este valor se le denomina Depreciación Biológica.

para
Objetivo fase de recría:
Iniciar la Fase de Producción, en las mejores condiciones posibles (zootécnicas, fisiológicas, sanitarias, etc.), con un Costo de Capitalización que responda a las expectativas del área de reproductoras
y que permita cumplir con el requerimiento de producción de huevos incubables de acuerdo con el Planeamiento Estratégico y al Programa establecido para la Producción del Pollo de Engorde.
La Fase de recría es una etapa crítica por su gran repercusión en la producción de huevos fértiles y pollitos BBs de engorde.
Debe planificarse de la mejor manera posible y ser muy conscientes que “ahorros“en el proceso (valor absoluto), puede generar pérdidas (valor relativo), en nuestra producción final objetivo:
Orientada a una óptima producción del pollo de engorde, traducida en Kilos de carne, que serán destinados a la comercialización como pollo vivo o como carne procesada.

Fase de producción:
Es Importante producir el mayor número de huevos fértiles de calidad con el menor costo posible (lógicamente por ave alojada), lo cual incidirá directamente en la calidad del pollito BB y en su respuesta productiva en el campo.
Durante el período de producción, los costos totales generados se distribuyen de acuerdo con las cantidades producidas de huevo fértil, por cada lote de producción.

De esta manera, podremos establecer el costo del huevo incubable, por lote, edad, raza, y cualquier otra variable requerida, y establecer el costo promedio del periodo.
Materiales directos
1. Costo de pollito BB
Reproductor
2. Consumo de alimento
Balanceado

Mano de obra directa
Costos indirectos de Fabricación
1. Materiales auxiliares
En resumen, es muy importante cumplir con el requerimiento de huevos incubables de nuestro cliente inmediato (área de Incubación), en número, en calidad y optimizando el costo de transferencia, que será el punto de partida para el costo del pollito BB.
Consolidación de Información
Sistema de Control de Produción y Costos
Distribución de los costos Indirectos
Base de distribución: Aves días
Costo de Activo
Biológico
Costo de Huevo Incubable


Roxell ofrece una solución completa de 360° para avicultores y porcicultores. Nuestros productos se basan en tres valores fundamentales: Innovación, Durabilidad, Eficiencia. Desde los sistemas de alimentación automatizados hasta la circulación del aire y el control climático, ayudamos a que su granja funcione de forma óptima.
Sistemas de alimentación avanzados para una cantidad y composición precisas.
Sistemas de bebederos que proporcionan agua limpia y fresca para animales sanos.
Sistemas de anidación confortables para reproductoras de pollos de engorde y ponedoras comerciales.
Sistemas de calefacción energéticamente eficientes para un rendimiento durante todo el año.
Sistemas de ventilación para un flujo de aire y una temperatura óptimos.
Controladores de alimentación Smart para un control total de la explotación y conectividad.
Elija Roxell y maximice la eficiencia de su granja con soluciones que crecen con sus necesidades.
¿Quiere saber más?


Hay muchos factores que interrelacionan para optimizar la producción de huevos fértiles por ave alojada.
Por lo tanto, el control de estos factores (peso corporal, condición corporal, status sanitario, programa de nutrición y alimentación en concordancia con la línea genética, control de apareamiento, densidad de crianza, etc.), es de vital importancia para alcanzar los objetivos del área de reproductoras.
Al igual que en el caso de la planta de alimentos, las inversiones en el área de reproductoras, deben ser evaluadas en forma permanente y correlacionadas con los resultados en campo.
Inversiones en Infraestructura, ventilación, Iluminación, comederos, bebederos, nidos, calidad de cama y todo aquello que pueda optimizar el bienestar del ave (minimizando el estrés de la Producción), debe ser bien evaluada porque por lo general, hay una respuesta económica positiva a corto plazo.
COMPOSICIÓN DEL COSTO DE LEVANTE
Costos indirectos
BB
Gráfico 7. Elementos de costos - % Composición del costo levante.
Gráfico 8. Elementos de costos - % Composición huevo incubable.
Depreciación biológica Otros
Proceso de incubación de los huevos fértiles, proveniente de las granjas de reproductoras (enviados por Lotes), para la obtención de Pollos BB.

Inteligencia integrada, gran volumen de datos y total trazabilidad, mejora los resultados de incubación y contribuye a la reducción de los costos del proceso.
Un pollito bebé de óptima calidad es un factor crítico para alcanzar los estándares productivos que ofrecen las líneas genéticas actuales.
El proceso de incubación es hoy en día, una parte indiscutible de la cadena de producción avícola.
La vitalidad o la denominada "calidad" de los pollitos de un día de edad, se entiende como parámetro crítico para aprovechar todo el potencial genético del pollo de engorde.
Los pollitos de un día son un eslabón crucial entre la granja de reproductoras y la granja de pollos de engorde.
Hay muchos factores que interrelacionan para optimizar la producción de pollitos BB por ave alojada. Dependiendo de:
Tipo de Incubación (Etapa Única y/o Multi-Etapa).
Grado de Automatización de la Planta.
Infraestructura y condiciones operativas.
Condiciones Sanitarias propias de la Planta.

Imagen 3. Proceso de incubación de huevos fértiles.
Por lo cual, se deberán desarrollar los programas de operación, control, monitoreo y seguimiento, para alcanzar los objetivos del área de incubación.
Si contamos con huevos fértiles de óptima calidad, es prioritario obtener pollitos BB de la misma calidad. No hay excusas al respecto, y no es un proceso reversible.
Tenemos que desarrollar los métodos de trabajo que permitan obtener la mayor respuesta productiva en términos de incubabilidad y calidad de pollito BB, cumpliendo con lo establecido en el Planeamiento Estratégico y Operativo del área de Incubación.
Dependerá del tamaño de la empresa, de su capacidad de Inversión y de la rentabilidad del negocio, para mejorar la infraestructura de Incubación, orientada al uso de la nueva tecnología y al logro de una mejor respuesta productiva, traducida en optimizar el potencial genético y en mejores Indicadores y Costos Productivos.

Imagen 4 . Un pollito bebé de óptima calidad es un factor crítico para alcanzar los estándares productivos.
El uso de la nueva tecnología debe ser evaluado al detalle, partiendo de la línea base, y proyectando los nuevos indicadores y costos productivos, con la finalidad de estimar el periodo de retorno de la inversión.
Esto puede variar de una empresa a otra, porque las condiciones pueden ser diferentes y como consecuencia, la respuesta también puede ser diferente.

Materiales directos
1. Costo de huevo incubable
Mano de obra directa
Costos indirectos de Fabricación
1. Materiales auxiliares
2. Energía Eléctrica
3. Depreciación
4. Mantenimiento
5. Mano de Obra ind.
6. Otros gastos
Gráfico 9. Proceso de costo de incubación.
Durante el período de Incubación, los costos totales generados se distribuyen de acuerdo con las cantidades producidas de pollito BB, por cada lote de producción.
De esta manera, podremos establecer el costo del pollito BB, por lote, edad, raza, y cualquier otra variable requerida, y establecer el costo promedio del periodo.
En resumen, es muy importante cumplir con el requerimiento de pollitos BB de nuestro cliente inmediato (área de engorde), en número, en calidad y optimizando el costo de transferencia, que será el punto de partida para el costo del pollo de engorde.
En general, son procesos continuos y acumulativos de costos y gastos operativos, que se distribuirán de manera lógica, ordenada y cumpliendo con las normativas contables vigentes.
Consolidación de Información Distribución de los costos Indirectos
Sistema de Control de Produción y Costos
Costo de Producción
Pollito BB de Engorde Base de distribución: Huevo días
10. Elementos de costos - % composición costos incubación de proceso de incubación.
11. Elementos de costos - % Composición de costos.









